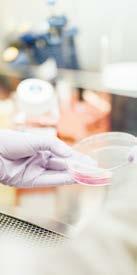

Director: Jorge Blanco Carvajal
![]()




Director: Jorge Blanco Carvajal


Por: Martha Medina
Ante los malos resultados que el programa “Durango de Rol” ha tenido para varios restaurantes que se encuentran en la zona donde se realiza este programa, la Cámara Nacional de la Industria Restaurantera (Canirac) pedirá a las autoridades que revisen el cierre de calles, pues hay más de 5 restaurantes afectados por la caída en las ventas y uno ya anunció su decisión de cerrar los domingos. La presidenta de Canirac, Adriana Porras Zubiría, informó que durante una reunión con los principales restauranteros que están en la zona donde se desarrolla el programa, para conocer los resultados que tuvieron este domingo, “la verdad no son muy
buenas noticias, únicamente los que están enfrente de la Plaza de Armas son los que reportan un buen flujo de clientes, pero tristemente tuvimos un restaurante que tomó la decisión de cerrar los domingos”.
La empresaria consideró que se trata de algo grave para la Cámara, pues que un restaurante haya tenido que tomar esa decisión, evaluando sus ventas, no solamente afecta al establecimiento, sino también la cadena que se deriva, pues los meseros verán afectados sus ingresos.
Explicó que se trata del restaurante “El Esquilón”, que se encuentra en el Corredor Hidalgo, que es de los más impactados por el citado programa, donde los establecimientos buscan estrategias
Solicitan cerrar fronteras a ganado de Centroamérica
información en páginas interiores
Vigilan que México se mantenga libre de influenza aviar
para captar más clientes, como sacar mesas a la calle, aunque por la mañana el menú que pueden consumir las personas que pasean por las calles no es tan fuerte, tal vez compren un jugo, un café, mientras el concepto que tiene un restaurante de un desayuno formal, está dirigido para clientes adultos que llegan en su coche, que pueden dejar a personas mayores e ir a un estacionamiento. Sin embargo, no hay acceso a los estacionamientos, dijo la presidenta de Canirac, al indicar que al menos 5 restaurantes presentaron ventas muy bajas, e incluso los clientes de mucho tiempo de estos restaurantes, ya anunciaron su decisión de no regresar, por las dificultades de acceso que se presentan.
Ante tal situación, Adriana Porras puntualizó que se dialogará con las autoridades para exponer esta situación, que se basa en actos concretos y con una propuesta que pueda ser funcional.

Además de lluvias y viento moderado en algunas localidades
Un nuevo frente frío, el número 7 de la temporada, avanza sobre el Noroeste mexicano y podría dejar mañanas gélidas en Durango, además de lluvias y viento moderado en algunas localidades.
De acuerdo con pronósticos meteorológicos divulgados por medios que consultan fuentes oficiales del SMN-Conagua, el Frente Frío 7 llegará entre el martes 14 y el jueves 16 de octubre, impulsado por una corriente en chorro subtropical. Se anticipan descensos en la temperatura, así como rachas de viento que podrían alcanzar entre 40 y 60 km/h en ciertas regiones del Norte del país.
Para Durango se prevén chubascos puntuales fuertes (entre 25 y 50 mm) durante el miércoles 15, bajo la influencia directa del Frente Frío.
Aunque las noticias y medios citan que la Sierra de Durango está dentro de los estados con mínimas entre 0 y 5°C en la madrugada del miércoles 15 de octubre, no hay aún un boletín técnico del SMN que confirme con certeza
ese valor para todas las zonas del estado.
Sin embargo, los informes indican que las temperaturas mínimas de 0 a 5°C podrían presentarse en zonas serranas de Durango, junto con Sonora, Chihuahua, Estado de México, Tlaxcala, Puebla, Hidalgo y otros más.
Para la capital del estado (Durango ciudad), el pronóstico local (Meteored / tiempo.com) sugiere que para el miércoles 15 se esperan máximas de 26°C y mínimas de 13°C. Esto indicaría que el efecto del Frente Frío sería más notorio en zonas altas que en la zona urbana.
En las partes más altas de montañas duranguenses es donde el frío se acentuará más y podría sentirse cerca de los 0°C, especialmente en las madrugadas. El viento, aunque no tan intenso como en la región Noroeste, podría reforzar la sensación térmica fría en zonas abiertas o con menor protección vegetal. Las lluvias contribuirán a humedad ambiental que podría aumentar la sensación de frío durante las primeras horas del día.
Mientras que no haya respuesta a casos de desapariciones: Diputada
Ante la situación que se presenta con las desapariciones en Mazatlán, que han sido denunciadas, “desde mi punto muy personal de vista, yo en estos momentos no viajaría a Mazatlán, yo, Gabriela, sugeriría a quien me preguntara de conocidos o amigos, que éste no es el momento para realizar este tipo de viajes”, dijo la diputada Gaby Vázquez Chacón.
Mexicano Del Toro, el tercer mejor ciclista del mundo

El ciclista mexicano Isaac del Toro es considerado el tercer mejor pedalista del mundo, de acuerdo al ranking oficial de la Unión Ciclista Internacional (UCI). El “Torito” aparece en la lista detrás del esloveno Tadej Pogacar y el danés Jonas Vingegaard. La temporada de Isaac ha sido impresionante con 15 victorias, dos top 8 en el Campeonato Mundial y el segundo lugar en el Giro D´Italia.
Al referirse a los casos señalados de duranguenses que desaparecieron al dirigirse hacia el puerto ubicado en el estado de Sinaloa, la legisladora panista recordó que un grupo de madres buscadoras ha señalado que hay hasta 80 personas desaparecidas cuando viajaban hacia Mazatlán, aunque reconoció que se trata de casos que no fueron denunciados de manera formal.
“Es importante hacer un llamado a las familias para que realicen la denuncia correspon-
diente, es decir como tal, el propio Estado tiene formalmente 8 denuncias establecidas, hechas, sin embargo ellos comentan alrededor de 80, pero no hay denuncias”, dijo la legisladora. Cuestionó la falta de avances en las denuncias que se han presentado hasta el momento, “es un tema lamentable, preguntaría al gobierno de Sinaloa ¿qué hacen, cuántos duranguenses más tienen que desaparecer, cuántos sinaloenses más tienen que desaparecer, cuántas personas más?”, pues recordó que va más de un año donde el vecino estado vive una terrible inseguridad, en el cual por supuesto los duranguenses que han desaparecido ha sido en el tramo hacia Mazatlán, para exigir que las fiscalías den una respuesta a esta situación, pues las familias señalan que no tienen un acompañamiento del gobierno, de la Fiscalía, ni una comunicación constante.

Consideran que éste no es el momento para realizar este tipo de viajes.
Por: Jorge Blanco C.
+ México ya no es atractivo para los chinos + Cierran ya sus agencias distribuidoras + Durango, el más perjudicado en el país + Creen que el nearshoring renacerá pronto + Echan a pedradas al alcalde de Poza Rica
“Marinos y federales buscan a alguien allá por las instalaciones de la Feria. Ay, nanita…” Anónimo
México ya no es atractivo para los inversionistas chinos. No nada más se están llevando sus fábricas a otras partes, sino que también están cerrando sus distribuidoras en nuestro país CEROS.- O sea, ni Chirey ni ninguna otra marca creará una plaza nueva de empleo en Durango, mucho por los aranceles de Donald Trump y otro mucho por los aranceles que ha dispuesto el Gobierno de México a las fábricas asiáticas…..ARMADORAS.- El sueño de ya saben quién de traer una armadora de carros a nuestra capital, obviamente, seguirá siendo sueño, al menos mientras dure Trump en la Presidencia de los Estados Unidos, porque es el principal creador de los nuevos paquetes impositivos ADIÓS.- Las fábricas asiáticas de autos eléctricos traen una marcación perruna, como en el futbol, por tanto, mientras no le quite Donald los nuevos impuestos a sus autos, no podrán entrar a los Estados Unidos, donde Tesla, de Elon Musk, es el dueño absoluto del mercado en la Unión Americana con sus vehículos. Algo que en el fondo es lo que está haciendo Trump con su cierre de las fábricas chinas, proteger a Tesla por los más de 200 millones de dólares que le regaló el primo Elon a Donald para su campaña. Allá sí que “amor con amor se paga…”, los autos de Space X se seguirán vendiendo como pan caliente y los chinitos van a tener que conformarse con ver la aceleración en las ventas de Tesla y de cuyas utilidades no pueden alcanzar nada…..TÁCTICAS.- Los que se identifican con los movimientos económicos, aseguran que el nearshoring no precisamente está muerto para México y Durango, que en un tiempo prudente pudiesen modificarse las reglas del juego, pero…las urgencias de nuestro estado son para ayer, no para mañana y mucho menos para tres o cuatro años. Carajos, tan bien que íbamos, como dijo don Plácido Rodríguez cuando sus refrescos eran los únicos que se vendían en Durango, riquísimos por cierto, porque siempre creímos que las fábricas anunciadas por el gobierno sí se instalarían acá, y por mala suerte, las marcas chinas están buscando otros puntos estratégicos en el mundo para estar cerca de los Estados Unidos, que sigue siendo el mercado más apetitoso para la industria en términos generales. O sea, no está lejano el día en que Trump prohiba las marcas asiáticas y las consecuencias serán mucho peor. Donald lo que quiere es que las fábricas se instalen en los Estados Unidos, para que le generen más impuestos al gobierno. Y no anda tan errado el oxigenado, solo que allá en la Unión Americana tienen que pagar mejores sueldos y consumir productos gringos, precisamente lo que no quieren hacer los asiáticos, justo para no sacrificar sus utilidades proyectadas en lo global AGUAS.- La tragedia que viven los veracruzanos es mucho más grave de lo que suponíamos a la distancia, peor ayer que la gobernadora Rocío Nahle dijera que el río Cazones “se desbordó ligeramente…”, a pesar de que siguen circulando en redes videos de las enormes e incontrolables avenidas de agua y que van arrastrando lo mismo personas que animales, además de muebles y otras cosas de la gente. Quién sabe por qué intentó negar la magnitud del desastre, pero habló tal vez de otra parte de México y no del estado que desgobierna. Nada más para darnos una idea de la magnitud de las afectaciones, es posible asegurar que nadie tiene una idea aproximada de los perjuicios, además de los 192 estudiantes de la Universidad del Valle que resultó la escuela más afectada, aunque hay muchos más muertos en todo el estado. O la otra, si se desbordó “ligeramente”, ¿qué no pasará cuando se desborde poquito más de lo ligero?.....APEDREADO. - El alcalde de Poza Rica, Fernando Remes, hizo un recorrido por las zonas inundadas de su municipio y lo echaron a pedradas y puños de lodo a su vehículo, del que nunca se bajó por no ir a mojarse el pantalón. Las mentadas brotaron de forma unánime como si fueran chocolates. Y así le irá a otros que andan por las mismas.
Saludos
En Durango, es el diario publicado por Editorial Contacto hoy, S. A. de C. V., todas las tardes de lunes a sábado, en la ciudad de Durango, Dgo., México. Fundado el 30 de enero de 1998. Impreso en Talleres, Oficinas y Redacción ubicados en: Blvd. Armando del Castillo Franco No. 820, Fracc. La Loma, C.P. 34058. Tels: 128-0717 y 128-0647. Correo electrónico: contactohoy@prodigy.net.mx. Web: www.contactohoy.com.mx
Jorge Blanco Carvajal Director General
Ricardo Güereca Reyes Jorge Adrián Blanco Barraza Jefe de Redacción Jefe de Información
Susana Blanco Barraza Erika J. Blanco Barraza Redes Administración
Reporteros: Martha I. Medina Valenzuela, Andrei Maldonado, Hugo Burciaga. Diseño: Arturo Navarrete
Asesor Jurídico: Miguel Ángel Ortiz Gallegos
Características 224 153703 autorizado por el Servicio Postal Mexicano. Reserva de Derecho al uso exclusivo: 04-2018-101714083700-101 expedido por el Instituto Nacional del Derecho de Autor. Certificado de Licitud de Título y Contenido No. 17212 expedido por la Comisión Calificadora de Publicaciones y Revistas Ilustradas de la Secretaría de Gobernación.

La subsecretaria de Comunicaciones y Transportes, Tania Carro Toledo, afirmó que el autotransporte federal, de carga y pasaje, es uno de los principales motores de la economía del país al generar más de 2 millones de empleos directos e indirectos. Destacó la importancia de la Dirección General de Autotransporte Federal (DGAF), ya que, a través de ella, dijo, se impulsan y generan acciones enfocadas a fortalecer la seguridad y el control para las y los operadores, en beneficio de la ciudadanía.
La importancia del autotransporte federal “radica en ser un pilar para el comercio, el turismo, el empleo y la industria, abarcando desde el transporte de mercancías, alimentos, medicamentos hasta la movilidad de las personas en más de un 90 por
ciento a nivel nacional; mueve el 82 por ciento de carga terrestre. Es esencial porque abastece a la industria, comercios y servicios”, enfatizó.
Al participar en la conferencia “Diálogo con Ingenieros”, organizada por el Colegio de Ingenieros Civiles de México (CICM), el director general de Autotransporte Federal, Luis Ruiz Hernández, anunció que en breve y, en coordinación con la Secretaría de Energía (SENER) y la Agencia de Seguridad, Energía y Ambiente (ASEA), se realizarán las primeras inspecciones a las unidades que transportan Gas Licuado de Petróleo (LP).
Indicó que también se trabaja para reducir riesgos a la población y el medio ambiente y mencionó que, conjuntamente, con la Secretaría de Energía se desarrolla
¿Rentar o pagar
un sistema de monitoreo de las unidades que transportan gas. “Inicialmente es para gas, continuaremos con hidrocarburos, y después con todo el transporte de sustancias peligrosas”, comentó.
Finalmente, detalló que mediante GPS habrá seguimiento de las unidades de transporte y distribución de Gas LP para verificar su trayecto; además de que se revisará que cuenten -de forma obligatoria- con reguladores de velocidad.
Previamente, se deberá realizar el mantenimiento de las unidades y la certificación de los conductores; con este modelo de cumplimiento de las obligaciones de seguridad, sostuvo que se reduce la probabilidad de accidentes.
Ciudad de México (Agencias).- En lugar de ver al alquiler como un gasto, puede ser una herramienta que ofrece flexibilidad ante la realidad del mercado inmobiliario en México.
En un contexto de aumento constante en los precios de vivienda, cada vez más jóvenes enfrentan una pregunta que define su futuro financiero: ¿conviene más rentar o pagar una hipoteca?
En México, la respuesta parece inclinarse hacia la primera opción, no por preferencia, sino por necesidad. El encarecimiento de los inmuebles, los bajos salarios y los enganches cada vez más altos han hecho que acceder a una casa propia sea un objetivo lejano para muchos.
Según datos de la Sociedad Hipotecaria Federal (SHF), el precio promedio de una vivienda en México alcanzó 1.8 millones de pesos durante el primer trimestre del 2025, lo que representa un incremento de 8.7% respecto al año anterior y más de 53% desde el 2020.
En contraste, el salario promedio de un joven profesionista ronda los 8,200 pesos mensuales, una cifra que ha crecido muy por debajo del valor de los inmuebles. De acuerdo con la iniciativa Revive y la Asociación de Vivienda en Renta (AVER), un joven necesitaría destinar más de 17 años de su sueldo íntegro —sin gastar en nada más— para poder comprar una casa de precio promedio en el país.
“En lugar de ver la renta como un gasto, es más productivo considerarla una herramienta que ofrece flexibilidad. El arrendamiento no es un gasto muerto, es una estrategia de vida y finan-

ciera”, explicó Carlos Valladares, miembro del consejo de la AVER. Uno de los mayores retos para acceder a una vivienda es el enganche. Las instituciones financieras suelen requerir entre 10 y 20% del valor del inmueble, lo que equivale a entre 170,000 y 340,000 pesos para una casa promedio. Este monto representa años de ahorro para la mayoría de los trabajadores jóvenes.
Aun así, algunos expertos sostienen que la hipoteca es una buena alternativa según el perfil de cada persona. Mientras que rentar permite construir un patrimonio a través del ahorro, sin comprometer la liquidez. “Con una hipoteca estás comprando un activo; con la renta se paga un derecho de uso de algo que no te genera valor. Esto no necesariamente está mal, todo depende de las prioridades y el momento de vida de cada uno”, apuntó Gonzalo Palafox, director ejecutivo de crédito hipotecario de Banamex.
El especialista explicó que algunos compradores prefieren des-
tinar sus ingresos a un negocio o a inversiones que a largo plazo podrían rendir más que la plusvalía de una casa, mientras ahorran lo suficiente para una hipoteca. Aunque rentar puede ofrecer flexibilidad, el aumento en los precios también afecta a este segmento. Según Valladares, alrededor de 18% de los jóvenes que viven solos destinan más de 40% de sus ingresos al pago de alquiler, lo que limita su capacidad de ahorro y retrasa sus metas financieras. En ese sentido, la renta puede funcionar como un puente hacia la compra, siempre que se acompañe de una estrategia de ahorro sostenida y planeada. Para los expertos, la brecha entre los salarios y el precio de la vivienda ha generado un cambio cultural en la forma en que los jóvenes conciben el acceso al patrimonio. Hoy, tener una casa propia es todavía una aspiración, pero rentar ya no se percibe como un fracaso, sino como una alternativa financiera ante un mercado inmobiliario retador.
Como parte de las acciones para atraer más inversión extranjera y fortalecer las cadenas de suministro de América del Norte, la Secretaría de Economía participó del 7 al 9 de octubre en SemiconWest Phoenix 2025, el evento líder mundial en la industria de semiconductores.
Con el pabellón “México”, la dependencia promovió las ventajas competitivas del país en toda la cadena de valor del sector: desde el diseño y los materiales, hasta el testeo, empaquetado y distribución de componentes electrónicos. La feria reunió a más de 43 mil asistentes y 1,200 expositores, brindando un espacio estratégico para sostener encuentros de alto nivel con empresas y gobiernos de los principales centros tecnológicos del mundo.
Durante la misión, se llevaron a cabo reuniones de negocio con empresas estadounidenses como Qualcomm, Towa y Reytek. La SemiconWest tuvo también paneles encabezados por TSMC,
Nvidia y la gobernadora de Arizona, Katie Hobbs, quien próximamente realizará una visita a México.
La participación mexicana también permitió presentar las oportunidades regionales del país ante instituciones y empresas de Alemania, Francia, Corea, Japón y Taiwán, consolidando el liderazgo de México como plataforma de manufactura avanzada y nodo estratégico del ecosistema de semiconductores norteamericano.
En el marco de la feria, el Consulado General de México en Phoenix, encabezado por el Cónsul General Jorge Mendoza, organizó un “showcase” de inversión para promover proyectos de los estados de Sonora, Chihuahua y Puebla, con la presencia de representantes de Baja California y Jalisco, quienes también exploraron oportunidades de colaboración industrial en el marco de la SemiconWest.
Asimismo, la delegación

mexicana sostuvo reuniones con autoridades y cámaras empresariales de las ciudades que integran la cadena logística del suroeste de Estados Unidos, como Las Cruces, Maricopa, Phoenix, Schertz (Texas), Chandler y Prescott, for-
taleciendo los lazos binacionales para el desarrollo de nuevos corredores tecnológicos. De parte de la Secretaría de Economía, la misión fue encabezada por Diego Flores, responsable del Sector de la Industria Electrónica y Digital, y Jesús Val-
dés, responsable del Eje Transversal de Promoción Económica en el Extranjero, quienes subrayaron que esta participación reafirma el compromiso de México con la innovación, la competitividad y la integración productiva regional.
Ciudad de México (La Jornada).- En septiembre de 2025, el costo de los productos que se consideraron en la canasta alimentaria presentó un crecimiento anual de 3.6 por ciento en el ámbito rural, por debajo de la inflación general anual (3.8 por ciento), mientras que, en el caso del urbano, superó a la inflación, al subir 4.7 por ciento, revelaron datos del Instituto Nacional de Estadística y Geografía (Inegi). Los rubros de alimentos y bebidas consumidas fuera del hogar, así como el de bistec de res (de cualquier parte que se saque), fueron los que más contribuyeron al incremento anual del valor monetario de la canasta alimentaria. El rubro de alimentos y bebidas consumidas fuera del hogar presentó mayor incidencia en el ámbito urbano (un incremento anual de 7.6 por ciento); el rubro de bistec de res (de cualquier parte

que se saque), presentó mayor incidencia en el ámbito rural (18.7 por ciento más en 12 meses). En este, la molida de res fue el tercer rubro que más contribuyó al aumento de la canasta alimentaria.
En el urbano, fue la leche pasteurizada de vaca (un alza de 9.2 por ciento anual en septiembre).
Por su parte, los valores monetarios de la canasta alimentaria y la no alimentaria fueron de 3.4
Ciudad de México.- Todo parece indicar que esta semana, a más tardar el 17 de octubre, los diputados federales se alistan para votar la Ley de Ingresos propuesta en el Paquete Económico 2026. Hay una clara insistencia en aprobar el aumento al IEPS a las bebidas saborizadas y un doble incremento al cigarro, medidas que engalanarán la tradicional cuesta de enero, cuando se presenta una cascada de aumentos de precios en prácticamente todos los productos del mercado.
La intención de votar a favor este aumento se sostiene en dos ideas: 1.- Que con ello disminuirá el consumo de los productos gravados. 2.- Que lo recaudado se destinará a un fondo a favor de la salud pública.
Sin embargo, la evidencia de los últimos 11 años demuestra todo lo contrario: a) No disminuyó el consumo de los productos gravados, b) no se etiquetó lo recaudado para salud; ese dinero terminó en gasto corriente, y c) no se contuvieron las enfermedades crónicas; al contrario, se incrementaron. El aumento al IEPS será el detonante de una ofensiva direc-

ta contra el poder adquisitivo de la gente. Este impuesto tendrá un doble efecto negativo: por un lado, el impacto directo en los bolsillos de los consumidores y por otro, el efecto en cadena que provocará al encarecer el resto de los productos del mercado. Por ello, la Alianza Nacional de Pequeños Comerciantes (ANPEC) reitera su rechazo al aumento del IEPS, por ser un impuesto fallido e ineficaz, por ser un impuesto inelástico (se ha probado que no cambia los hábitos de consumo de la población) y ser un impuesto regresivo (golpea directamente a los sectores más vulnerables y mina aún más el poder adquisitivo de las fami-
lias mexicanas). En suma, porque resulta evidente que esta medida fiscal es meramente recaudatoria. “Vivimos un momento de incertidumbre económica, con un índice de confianza del consumidor a la baja, y una inflación que no cede, con tres meses consecutivos al alza. En este contexto, aumentar impuestos es una medida profundamente inflacionaria que agravará la situación económica del país”, destacó Cuauhtémoc Rivera, presidente de ANPEC. A causa de esto, ANPEC hace un llamado a los diputados federales a votar en conciencia, a atender y ser sensibles de la realidad social que prevalece y a no repetir páginas caducas de la historia ya superadas.
por ciento en el ámbito rural y 3.8 por ciento en el urbano. El incremento en el ámbito rural fue menor a la inflación general anual (3.8 por ciento) y en el ámbito urbano fue similar. Las líneas de pobreza por ingreso (LPI) se conforman de los alimentos (canasta alimentaria) y de bienes y servicios (canasta no alimentaria). Respecto a los productos que más contribuyeron al cambio anual de las LPI fueron los
de la canasta alimentaria en los dos ámbitos; esta incidencia fue mayor en el urbano (63.9 por ciento) que en el rural (56.5 por ciento). Respecto a la canasta no alimentaria, destacaron los rubros de cuidados personales y de educación, cultura y recreación por ser los de mayor incidencia en el ámbito rural. En el urbano, por su parte, destacaron los de educación, cultura y recreación, así como los de cuidados personales.
¿Cómo puedo registrarme a una Afore y cuántas existen en México?
Ciudad de México (Agencias).- Si entraste a trabajar y comenzaste a cotizar hace poco, es indispensable registrarte en una Afore. La Administradora de Fondos para el Retiro es una institución financiera en México que se encarga de administrar los fondos de ahorro de los trabajadores. A largo plazo, la Afore genera rendimientos, lo que sirve para garantizar tu patrimonio a futuro. Primero debes elegir una Administradora de Fondos para el Retiro (Afore) y registrarte para comenzar a almacenar tus ingresos y aportaciones en tu cuenta y asegurar el bienestar de tu futuro: Elige una Afore: para una selección informada puedes evaluar las opciones, utilizando las herramientas que la Consar pone a disposición de los ciudadanos. Contacta a la Afore: contacta y solicita la visita de sus agentes promotores o acude a cualquiera de sus sucursales.
Tramita tu registro: la Afore conformará tu "Expediente de Identificación Electrónico", que llevará algunos datos personales como la CURP, RFC, Número de Seguridad Social del IMSS, identificación oficial vigente, comprobante de domicilio, una fotografía digital, firma biométrica (huellas digitales) y firma manuscrita digital. Responde a la solicitud de registro: confirma tus datos personales y acepta la solicitud. Hasta esta fecha hay un total de 10 instituciones financieras Afore, reguladas por la Comisión Nacional del Sistema de Ahorro
para el Retiro (Consar), entre ellas figuran: Banco Azteca, Banamex, Coppel, Inbursa, Invercap, Pensionissste, Principal, Profuturo, Sura, XXI Banorte. Para ubicar en qué administradora se encuentra registrada su Afore, los usuarios pueden de manera gratuita a través de la línea telefónica de Sartel, comunicándose al 55 13 28 50 00. También pueden consultarlo por internet, ingresando al portal "AforeWeb" en la sección "Localiza tu Afore". Al entrar al sitio web, sigue las siguientes indicaciones: Entra al portal aforeweb. com.mx/localiza-tu-afore.
Proporciona tu Número de Seguridad Social (NSS) del IMSS o tu Clave Única de Registro de Población (CURP) en caso de cotizar para el ISSSTE.
Ingresa un correo electrónico al que se le enviará la información. Cabe señalar que en la página solamente se puede realizar una consulta diaria.
Otro método para consultar la institución financiera a la que perteneces es a través de la aplicación para celular "AforeMóvil": Descarga la aplicación "Afore Móvil" en tu celular.
Regístrate con tu CURP, correo electrónico y número celular. Genera tu contraseña de acceso, la aplicación verificará tus datos y en un plazo de 48 horas tendrás acceso.
Inicia sesión, ingresa al menú "Mi cuenta" y ve a la sección "Mi ahorro" para realizar la consulta.
En cumplimiento de la política educativa del Gobierno de México para fortalecer la Educación Media Superior impulsada por la Presidenta Claudia Sheinbaum y garantizar que ningún joven se quede sin estudiar por falta de espacio, el secretario de Educación Pública, Mario Delgado Carrillo, realizó durante el último mes visitas de supervisión por algunos estados para constatar los avances en la construcción, ampliación y reconversión de lo planteles contemplados en una primera etapa en el nuevo Bachillerato Nacional de la Nueva Escuela Mexicana (NEM).
En el Estado de México colocó la primera piedra del Centro de Bachillerato Tecnológico Industrial y de Servicios (CBTIS) No. 295, en el municipio de Ecatepec, el cual beneficiará a mil 85 estudiantes. En Ixtapaluca, recorrió las instalaciones del nuevo CBTIS No. 296, cuya edificación representa una inversión de 67 millones de pesos. Durante su visita, verificó el avance de obra y la entrega de mobiliario escolar, acciones que forman parte de los ejes estratégicos del Plan Integral de la Zona Oriente del Estado de México en favor de niñas, niños, adolescentes y jóvenes de los diez municipios que integran la región: Chalco, Chicoloapan, Ecatepec, Ixtapaluca, La Paz, Nezahualcóyotl, Texcoco, Tlalnepantla y Valle de Chalco.
Durante su visita a Nuevo León, el titular de la SEP supervisó los trabajos de construcción de los nuevos CBTIS No. 298 y
299, ubicados en los municipios de Juárez y García. Estos planteles se sumarán a la oferta educativa estatal con programas de vanguardia en Inteligencia Artificial, Robótica, Automatización, Electromovilidad, Ciberseguridad y Semiconductores, áreas prioritarias para la formación técnica y el desarrollo industrial del país. Asimismo, en el municipio de Ciudad Juárez, Chihuahua, recorrió el CBTIS 291, edificado en un terreno de 14 mil metros cuadrados donado por el gobierno municipal, lo que refleja la coordinación entre los tres órdenes de gobierno para ampliar la cobertura educativa en regiones con alto crecimiento poblacional. Esta obra beneficiará directamente a más de mil jóvenes del suroriente de la ciudad.
Durante las supervisiones, el secretario de Educación Pública dialogó con docentes, directivos y estudiantes sobre los avances del programa de expansión y las necesidades específicas de cada comunidad escolar. Señaló que, en Ixtapaluca, por ejemplo, la decisión de incluir la carrera técnica en Enfermería General en el CBTIS 296 fue resultado de la consulta con las autoridades locales y la comunidad educativa, atendiendo las demandas del sector salud en la región.
Subrayó que todas las obras se desarrollan bajo la supervisión técnica del Instituto Nacional de la Infraestructura Física Educativa (INIFED) y de la Secretaría de Infraestructura, Comunicaciones y Transportes (SICT), garanti-

zando transparencia en los procesos constructivos y cumplimiento de los estándares de seguridad, sustentabilidad y accesibilidad. Detalló que el programa de ampliación de la red de CBTIS forma parte del Plan Nacional de Expansión de la Educación Media Superior, que contempla la construcción de 20 nuevos planteles en todo el país, así como la ampliación de 35 bachilleratos y reconversión de 35 secundarias para ofrecer turnos vespertinos y aumentar la matrícula disponible. Con ello, la SEP avanza en el objetivo de ofrecer educación pública, gratuita y de calidad a todos los jóvenes del país.
En el marco del 46 aniversario de la fundación de la carrera de Ingeniería Bioquímica, el Instituto Tecnológico de Durango (ITD) inauguró el XX Simposio de Ingeniería Bioquímica, celebrado en el Aula Alejandro Guillot de la institución.
En representación del director, Dr. Guillermo de Anda Rodríguez, presidió la ceremonia la Dra. Adriana Eréndira Murillo, subdirectora académica, quien además realizó la toma de protesta de la nueva mesa directiva de la Asociación Civil de Estudiantes de Ingeniería Bioquímica (ACEIB), marcando así el inicio formal de las actividades de esta vigésima edición.
Durante la ceremonia también estuvieron presentes el Mtro. Héctor Antonio Flores Cabral, subdirector administrativo; la Mtra. Faviola Zúñiga Meraz, subdirectora de Planeación y Vinculación; el representante sindical de la Delegación D-V-36, José Antonio Gutiérrez Reyes, y la representación del Comité Ejecutivo de la Sociedad de Alumnos (CESA).
Programa incluye: talleres, cursos, conferencias y una muestra gastronómica.
y descubrir el potencial de cada uno de los estudiantes. El trabajo colaborativo y colegiado nos permite construir una comunidad que se impulsa y se enriquece mutuamente”, destacó.
Las actividades de este encuentro académico comenzaron con la conferencia magistral “Manejo de las emociones”, impartida por el Dr. Osiris Ochoa Serrano, quien ofreció una valiosa reflexión sobre el equilibrio emocional como herramienta esencial para el desarrollo profesional y personal.
El XX Simposio de Ingeniería Bioquímica se desarrollará del 13 al 17 de octubre, con un programa que incluye talleres, cursos, concurso de carteles, conferencias y una muestra gastronómica, que permitirá a las y los participantes compartir conocimientos, experiencias e innovación en el campo de la bioquímica.

Buscan que haya más mujeres en campos construidos socialmente por hombres.
romper la lógica de roles asignados y permitir que todos puedan hacer lo que realmente les interesa, así como construir políticas públicas educativas y programas concretos que contribuyan a reducir la brecha de género.
Para Rachel Brasser, embajadora adjunta del Reino Unido en México, atender esta brecha de género significa estimular la actividad científica desde la infancia, eliminar sesgos en las aulas, fortalecer programas de mentoría y transformar entornos de igualdad, por lo que es necesario invertir en la educación de niñas y mujeres.
La Mtra. Alma Citlalli Vázquez Moreno, jefa del Departamento de Ingenierías Química y Bioquímica, dirigió un mensaje de bienvenida en el que reconoció la dedicación y entusiasmo de la comunidad estudiantil y docente.
El Instituto Nacional de Bellas Artes y Literatura (INBAL), a través de la Subdirección General de Educación e Investigación Artísticas (SGEIA), y los Centros de Integración Juvenil (CIJ) firmaron un convenio de colaboración para impulsar actividades de prevención, tratamiento y capacitación en materia de adicciones y salud mental, con el objetivo de fomentar el bienestar emocional y social de las juventudes mexicanas. En la firma del documento participaron Alejandra de la Paz, directora general del INBAL, y
“Esta semana académica es una oportunidad para explorar nuevos horizontes de conocimiento, fortalecer habilidades
Carmen Fernández Cáceres, directora general de los CIJ, A.C. La titular del INBAL destacó la importancia de esta alianza interinstitucional, en la que se reconoce al arte como una herramienta de prevención, atención y acompañamiento emocional, así como un medio efectivo para fortalecer la salud mental, la convivencia y el bienestar integral. Señaló que: “El arte y la cultura tienen un impacto en la vida de todas las personas, sobre todo cuando enfrentan retos particulares. Es importante valorar las herramientas que ofrecen en
Este simposium representa un espacio de reflexión, actualización y fortalecimiento académico, donde convergen la experiencia del cuerpo docente, el entusiasmo del estudiantado y la colaboración con destacados especialistas del ámbito científico y tecnológico.
términos de reinserción, socialización, autoestima, prevención y salud mental, y poder impulsar acciones que apoyen la tarea que ustedes realizan”.
Por su parte, Carmen Fernández Cáceres subrayó que los CIJ han desarrollado diversas actividades artísticas, foros estudiantiles, conferencias y talleres sobre salud mental, autocuidado, regulación emocional y convivencia escolar, con la participación de estudiantes, docentes y familias. Agregó que, gracias a esta colaboración, jóvenes de los CIJ han podido acceder a experien-
Ciudad de México (La Jornada).- En México, tres de cada diez profesionales en áreas de ciencia, tecnología, ingeniería y matemáticas (STEM) son mujeres y solo hay 35 por ciento de investigadoras, de acuerdo con la Organización de las Naciones Unidas para la Educación, la Ciencia y la Cultura (Unesco). Durante un foro en la materia, funcionarios públicos y académicos coincidieron en que se debe trabajar en conjunto para elaborar una hoja de ruta en educación con perspectiva de género. En la sede de la Asociación Nacional de Universidades e Instituciones de Educación Superior (Anuies), durante el diálogo “Construyendo puentes hacia las STEAM con igualdad de género: una propuesta a la acción”, la secretaria de Mujeres, Citlalli Hernández indicó que esta administración desarrolla programas para reducir la brecha de género en las áreas de estudio de STEM, para que “cada vez haya más mujeres en campos construidos socialmente por hombres”.
Mencionó que la Nueva Escuela Mexicana obliga a pensar que el espacio educativo puede
cias culturales y espacios artísticos del INBAL, lo cual ha contribuido a su proceso de rehabilitación y reinserción social desde una perspectiva más humana y artística. Entre estas experiencias destacan los concursos nacionales
Tumbando Letras y Pintando el Medio Ambiente, en los cuales el INBAL participó como jurado y facilitador de espacios culturales, además de ofrecer talleres, visitas a museos y conciertos. Alejandra de la Paz comentó que este convenio permitirá ampliar la colaboración e invitó a iniciar un proyecto piloto en el
Consideró fundamental promover el empoderamiento femenino en campos como la programación y crear políticas institucionales que brinden igualdad de oportunidades para el ascenso profesional y el acceso a puestos de liderazgo.
Luis Alberto Fierro Ramírez, coordinador general de Fortalecimiento Académico Institucional de la Anuies, destacó que el diálogo internacional es una oportunidad para escuchar, aprender y construir propuestas concretas de acción.
ámbito teatral para abordar problemáticas sociales a través de la dramaturgia y la puesta en escena mediante talleres, generando un espacio de trabajo colectivo. Añadió que este instrumento busca promover un modelo colaborativo interinstitucional de prevención de adicciones y violencias, mediante estrategias artísticas, pedagógicas y de formación socioemocional adaptadas a la comunidad estudiantil del INBAL.
Es urgente que se cierre la frontera sur del país a la entrada de ganado procedente de países de Centroamérica, por el riesgo que representa para los productores mexicanos, como se ha visto con el cierre de fronteras por la plaga del gusano barrenador, señaló el diputado César Rivas. El legislador reconoció que la situación que se vive actualmente con el cierre de fronteras para la exportación de becerros hacia Estados Unidos afecta a todos los productores de ganado en general, no sólo a los de Durango y los estados exportadores, sino a los de todo el país.
Sin embargo, puntualizó que se trata de un problema que tiene solución, aunque para ello es necesario que el gobierno apoye y atienda el llamado que se le hace,
para que detengan la entrada de ganado en la frontera sur del país. Recordó que “al ganadero le urge estar en equilibrio, mandar su ganado a Estados Unidos y que se lo paguen a buen precio; mientras estén con el tema que está entrando por esa frontera ganado y lo peor, que esté infectado con plagas, vamos a tener este problema, nada ganamos con ser responsables si ellos no lo son”.
El diputado Rivas recordó que la pérdida económica en estos momentos ya es fatal, aunque se tiene la esperanza de que el gobierno federal cierre esas fronteras donde dejan entrar animales, becerros que tienen plagas, que están infectados y viene a dañar a los que se encuentran en el país.
Añadió que los productores ganaderos mexicanos han sido

Entrada de ganado representa riesgo para los productores mexicanos.
responsables, sobre todo en el caso de Durango donde se pone atención para que se hagan bien
las cosas, a ser enérgicos en las reglas de operación para estar listos para la exportación, por lo cual se
espera que el gobierno federal lo sea también y cierre las fronteras donde entra ganado con plagas.
Ante el inicio de la temporada otoño–invernal, la Secretaría de Agricultura y Desarrollo Rural (Agricultura) llama a reforzar las medidas de bioseguridad en las unidades de producción comercial y de traspatio, con el fin de mantenerlas libres de influenza aviar de alta patogenicidad (IAAP) AH5N1. Es fundamental notificar de inmediato cualquier anomalía que se observe en las aves, ya que en esta época migran desde Estados Unidos y Canadá especies que pueden portar el virus.
Con el propósito de proteger la producción avícola nacional, el Servicio Nacional de Sanidad, Inocuidad y Calidad Agroalimentaria (Senasica) intensifica las labores de vigilancia epidemiológica en las 32 entidades federativas. Con apoyo de la Secretaría del Medio Ambiente y Recursos Naturales, se realiza monitoreo de aves silvestres para detectar oportunamente la posible circulación

Llaman a productores a notificar cualquier sospecha y reforzar la prevención.
del virus y aplicar medidas preventivas.
Durante los últimos tres años, el personal técnico del Senasica ha atendido y confirmado casos aislados de IAAP en vida silvestre, principalmente cerca de humedales donde descansan aves migratorias, así como en producciones familiares sin infraestructura de bioseguridad.
Estos hallazgos no represen-
tan brotes ni afectan el estatus de México como país libre de influenza aviar, de acuerdo con los lineamientos de la Organización Mundial de Sanidad Animal (OMSA). No obstante, constituyen una alerta para reforzar la prevención, especialmente en regiones con presencia de aves migratorias.
El Senasica recuerda que las unidades de producción tecnifi-
cadas deben mantener óptimas condiciones de bioseguridad y evitar el ingreso de aves silvestres mediante mallas pajareras, puertas selladas y techos sin orificios. Asimismo, todas las granjas comerciales deben contar con una médica o un médico veterinario responsable autorizado (MVRA), encargado de verificar el cumplimiento de las disposiciones sanitarias y reportar de inmediato cualquier incremento en mortalidad o síntomas como disminución en la postura, diarrea, amoratamiento de crestas y barbillas, estornudos o secreción nasal.
El virus AH5N1 fue erradicado de México durante la temporada invernal de 2023 mediante el Dispositivo Nacional de Emergencia de Sanidad Animal (Dinesa), que implementó acciones estrictas de control y eliminación. Para reportar sospechas de enfermedades o plagas exóticas, el Senasica pone a disposición los
Conagua mantiene acciones de apoyo ante afectaciones provocadas por lluvias
El Gobierno de México, a través de la Comisión Nacional del Agua (Conagua), mantiene acciones de apoyo en las zonas afectadas por las recientes lluvias, con 84 brigadistas especializados y 45 equipos de atención de emergencia desplegados en los estados de Veracruz, Hidalgo, San Luis Potosí, Puebla y Querétaro.
En el estado de Veracruz, me-
diante 46 elementos y 33 equipos especializados, se han realizados acciones de bombeo de agua en zonas inundadas, suministro de agua potable, traslado de personas y apoyo logístico en las zonas con mayores afectaciones, priorizando en todo momento la seguridad de la población.
En Poza Rica, se han suministrado 150 mil litros de agua
potable a hospitales y colonias afectadas, además de desalojar más de 3 mil metros cúbicos de agua. Mientras que, en Pánuco, se han desalojado más de 730 mil metros cúbicos de agua, en beneficio de 12 mil habitantes.
En Álamo Temapache, continúa el traslado de habitantes a lugares seguros, con un camión especializado, así como la opera-

ción de una planta purificadora móvil para abasto de la población. En El Higo, brigadistas realizan traslados de personal médico y víveres mediante lanchas, mientras que en Tuxpan y Tihuatlán operan plantas potabilizadoras que garantizan el suministro de agua potable a más de 350 personas. Por su parte, en Hidalgo, 20 elementos y 9 equipos especializados brindan apoyo en los municipios de Metztitlán, Chapulhuacán y Pacula, donde se realizan traslados de personas y víveres, así como trabajos de reapertura de caminos con maquinaria pesada.
En San Luis Potosí, personal de la Conagua ejecuta un operativo de bombeo en el cárcamo Los Curros, municipio de Tamuín, con más de mil 200 metros cúbicos de agua desalojada. En los estados de Puebla y Querétaro, continúan las labores de apoyo en las comunidades afectadas. La Conagua refrenda su compromiso con la población afectada, trabajando en estrecha coordinación con autoridades estatales, municipales y de Protección Civil, conforme a los protocolos del Sistema Nacional de Protección Civil.
números 800 751 2100 y WhatsApp 55 3996 4462, disponibles las 24 horas, además de sus oficinas en todo el país.
Estiman 100 mil viviendas las afectadas por lluvias extremas
Ciudad de México (Agencias).- El número de viviendas dañadas en los cinco estados afectados por las lluvias extremas de la semana pasada podría ascender a 100 mil, adelantó la presidenta Claudia Sheinbaum Pardo; al respecto, advirtió que hasta el momento sólo se trata de una estimación, pues falta realizar el Censo del Bienestar que permitirá obtener datos oficiales, y que arrancó este mismo día. Desde su conferencia matutina en Palacio Nacional, la jefa del Ejecutivo federal precisó que el cálculo se realizó con base en “el número de viviendas que hay en cada municipio afectado y una estimación del porcentaje del municipio que fue afectado” aunque aclaró: “es una cifra totalmente preliminar. Hasta que no termine el censo no podríamos dar una cifra final”. En tanto, la secretaria de Bienestar, Ariadna Montiel Reyes, apuntó que el censo se realizará casa por casa con la participación de las y los servidores de la nación. “Se registra en este formato cada vivienda; y si en un predio hay más de una vivienda, se registra cada una de ellas. […] Se entrega en este registro un cintillo, que es el comprobante de que han sido censados, y con ese cintillo habrán de recibir sus apoyos”. Por ello, recomendó a la población conservarlo pues servirá para recibir todos los apoyos. De igual manera, anunció que esta semana se entregará el primer apoyo pues así lo instruyó la presidenta Claudia Sheinbaum. Detalló que los pagos se realizarán de manera semanal pensando en que sea de ayuda para los primeros trabajos de limpieza.
Después del censo, la Secretaría de la Defensa Nacional entregará un paquete que contiene distintos enseres domésticos como refrigerador, estufa, colchón, vajilla, un ventilador aseguró la funcionaria federal y garantizó que la ayuda llegará a todas las viviendas afectadas.
El cáncer de mama se mantiene como la principal causa de muerte en las mujeres de todo el país, mientras que en Durango las cifras oficiales indican que van 116 defunciones por esta causa en lo que va del año y se tienen 69 casos nuevos, de ahí la importancia de que continúen las campañas de prevención para detectar y tratar esta enfermedad.
La Asociación Civil Suma hace un llamado a las mujeres para que se hagan revisiones para la detección de cáncer y cuiden su salud, además de ofrecer 2 mil vales para la realización de ultrasonidos para detectar posibles irregularidades, los cuales se practicarán en las instalaciones del organismo.
Puntualizó que se tienen avan-
ces en lo que se refiere a la prevención y detección oportuna de cáncer de mama en las mujeres, además de que se cuenta con dos equipos para realizar las ecografías de mama y personal médico tanto para realizarlos, como para dar atención a temas de salud en las personas que la solicitan. Al mismo tiempo, informó que con los vales las mujeres podrán realizarse una ecografía de mamas, que en clínicas privadas tiene un costo de 800 a 1,200 pesos.
Recalcó que se cuenta con 2 equipos para realizar los estudios, así como con técnicos especialistas que acompañan en estas revisiones, que permiten detectar cualquier síntoma y no es tan invasivo.

Importantes campañas para detectar y prevenir esta enfermedad.
Invitaron tanto a integrantes de la asociación como al público en general, para que acudan a las
instalaciones de la misma, ubicadas en bulevar Felipe Pescador 612, para que soliciten su vale,
pues se entregarán hasta que sean agotados.
México reafirma su posición como referente internacional en investigación genómica y salud pública con la realización del Cuarto Simposio Internacional del Estudio Prospectivo de la Ciudad de México, una alianza entre el Instituto Nacional de Medicina Genómica (Inmegen) de la Secretaría de Salud, la Universidad de Oxford, la Universidad Nacional Autónoma de México (UNAM) y la Fundación Carlos Slim, que representa un importante avance en el estudio de la salud poblacional en América Latina.
Durante la inauguración, la líder del Laboratorio de Inmunogenómica y Enfermedades Metabólicas del Inmegen, Lorena Orozco Orozco, en representación del director general del Instituto, celebró el avance de esta colaboración científica que “ha colocado a México a la vanguardia de la investigación en salud poblacional, gracias al liderazgo y la confianza entre instituciones que son pilares del conocimiento y la educación a nivel mundial”. Orozco destacó que el Estudio Prospectivo constituye el acervo genómico más grande en América Latina, al haber integrado entre 1998 y 2004 a más de 150 mil personas adultas de Coyoacán e Iztapalapa. “Este proyecto repre-

Colaboración científica posiciona a México a la vanguardia de la investigación en salud poblacional.
senta una oportunidad sin precedentes para comprender cómo los factores sociales, genéticos, metabólicos y de estilo de vida influyen en las principales causas de enfermedad y mortalidad de la población mexicana”, subrayó. El especialista en salud pública de la UNAM, Roberto Tapia Conyer, recordó el origen del proyecto: “En 1994 parecía una meta imposible, pero demostramos que México tenía la capacidad científica para registrar, estudiar y comprender los determinantes de
salud de su población. Hoy contamos con una plataforma que reúne a más de 50 instituciones nacionales e internacionales y miles de investigadores que dedican su talento a salvar vidas”, aseveró. Tapia Conyer reconoció la confianza del profesor Sir Richard Peto y el papel fundamental de la Universidad de Oxford, que desde el inicio ha sido un socio clave. “Esta alianza permitió consolidar una red global de investigación que hoy publica en las revistas más prestigiosas del
mundo, como Nature y The New England Journal of Medicine. Es un legado científico que trasciende generaciones”, afirmó.
El líder del componente de salud poblacional del estudio y académico de la Universidad de Oxford, John Emerson, presentó los hallazgos más recientes que confirman la elevada prevalencia de obesidad y diabetes en México, así como su relación directa con la mortalidad por enfermedades cardiovasculares y renales.
“El Estudio Prospectivo de
la Ciudad de México se ha convertido en un recurso científico global, con acceso gratuito para investigadores de todo el mundo. Es un modelo de colaboración abierta que posiciona a México como un actor central en la investigación biomédica”, señaló.
El genetista y epidemiólogo de la Universidad de Oxford, Jason Torres, explicó que el estudio ha generado uno de los acervos genéticos más amplios del mundo, con información de más de 140 mil participantes y más de 30 millones de variantes genéticas identificadas, muchas de ellas exclusivas de la población mexicana.
“Estos descubrimientos permiten comprender mejor enfermedades como la diabetes tipo 2 y la obesidad, y abrir la puerta al desarrollo de tratamientos personalizados basados en la diversidad genética de México”, precisó.
El evento, celebrado en el Instituto Nacional de Medicina Genómica, reunió a investigadores, académicos, estudiantes y representantes de instituciones nacionales e internacionales. Además, incluyó una exposición científica de proyectos en marcha que fortalecen la investigación genómica y su impacto social.
Bogotá, Colombia (El Tiempo).- Como cada año, octubre se viste de rosa como el Mes de la Sensibilización sobre el Cáncer de Mama. Pero detrás del color hay una realidad que no deja de preocupar. Cada año, más de 2.3 millones de mujeres en el mundo son diagnosticadas con cáncer de mama, y 660,000 pierden la vida por esta enfermedad, según cifras del observatorio global Globocan. En las Américas, los casos superan los 490,000 nuevos diagnósticos anuales y las muertes sobrepasan las 106,000.
“Si no fortalecemos los esfuerzos de prevención y detección temprana, para el año 2040 las cifras podrían aumentar cerca de un 40 %”, advierte el doctor Wilson Cubides Martínez, director ejecutivo de la Liga Colombiana contra el Cáncer.
El cáncer de mama, explica Cubides, “es un crecimiento anormal de las células de la glándula mamaria. Hay dos tipos principales: los que se originan en los lóbulos, donde se produce la leche, y los que se desarrollan
en los conductos por donde esta circula hacia el pezón”. Cuando las células alteradas comienzan a multiplicarse sin control, forman masas o tumores que pueden invadir tejidos cercanos y, en algunos casos, propagarse a otras partes del cuerpo. Pero más allá de su definición médica, el cáncer de mama tiene un enemigo aún más peligroso: el desconocimiento. “Casi el 90 % de las mujeres con cáncer de mama en etapas tempranas no presentan ningún síntoma. Muchas creen estar sanas y, sin saberlo, ya están desarrollando la enfermedad”, explica el especialista. Contrario a lo que muchos creen, el cáncer de mama no se explica únicamente por los antecedentes familiares. “El 75 % de las mujeres diagnosticadas no tienen ningún factor de riesgo conocido”, señala el doctor Cubides. “Los factores predisponen, pero el cáncer de mama puede aparecer incluso sin ellos. Por eso, la vigilancia y la detección son fundamentales”. Entre los factores de riesgo
identificados, el experto destaca los siguientes:
Antecedentes familiares: “Cuanto más cercanos sean los familiares que hayan padecido la enfermedad, mayor será el riesgo relativo”, explica. Factores hormonales: tener la primera menstruación a edad temprana o una menopausia tardía aumenta la exposición a las hormonas que pueden influir en el desarrollo del cáncer.
Obesidad, sobrepeso y sedentarismo: “No hacer deporte es un factor de riesgo. La OMS recomienda al menos 150 minutos de ejercicio semanal, distribuidos como se prefiera, pero de forma constante”, señala.
Tabaco y vapeo: “Ojo con eso —advierte Cubides—. Los vapeadores tienen los mismos riesgos que los cigarrillos. Estamos trabajando en una ley para regularlos, porque causan daño real”.
Consumo excesivo de alcohol: cada vez más estudios confirman su relación directa con el cáncer.
Uso prolongado de anticonceptivos orales o terapias hormonales: “Su uso debe ser controlado por el médico. No se trata de prohibirlos, sino de evitar el abuso”, agrega. Para reducir los riesgos, la recomendación es clara: vida activa, alimentación saludable, no fumar, moderar el alcohol y mantener controles médicos regulares. Detectar el cáncer de mama a tiempo puede marcar la diferencia entre la vida y la muerte. Por eso, conocer el cuerpo y reconocer los signos de alerta es esencial. “El primer paso es observarse frente al espejo”, aconseja el médico. “Si hay asimetría entre los senos, retracciones en la piel o el pezón, enrojecimiento, aparición de bultos, secreción anormal o aumento visible de las venas, se debe consultar al médico inmediatamente”.
El autoexamen diario o al menos mensual es una herramienta valiosa. “La mujer se conoce mejor que nadie —dice Cubides—. Cualquier cambio, por pequeño que sea, debe tomarse en serio”.
El doctor Cubides resume la estrategia de detección en lo que llama “la triada que salva vidas”: Mamografía: “Es el método más importante. Debe realizarse cada dos años en mujeres mayores de 50 años. Es gratuita en Colombia dentro del Plan de Beneficios en Salud”, enfatiza. En mujeres menores de esa edad, puede hacerse por indicación médica. Examen clínico anual: a partir de los 40 años, incluso si no hay síntomas. “El examen médico permite detectar cambios que la mujer no siempre percibe”, añade.
Autoexamen: Una vez al mes. Es una práctica regular que no reemplaza los estudios médicos, pero complementa la vigilancia cotidiana. Cubides insiste en un punto clave: “En muchas regiones del país no hay mamógrafos. Por eso, el examen clínico y el autoexamen cobran aún más importancia. Pero no hay que confundirse: el autoexamen no reemplaza la mamografía ni la consulta médica”.
David Colmenares Páramo
Tecnología y ciberseguridad

El proceso de adopción tecnológica para la fiscalización es parte del fortalecimiento de la Nueva Auditoría.
Las Entidades Fiscalizadoras
Superiores (EFS) de América Latina y el Caribe enfrentamos desafíos estructurales para mejorar nuestras capacidades institucionales y ajustarnos presupuestariamente, para evitar lo que sucedió en Perú.
Por ello, los temas relacionados con la integración de la Inteligencia Artificial y las tecnologías digitales son cruciales como acción estratégica para fortalecer la rendición de cuentas.
Este enfoque centrado en la utilidad pública de las tecnologías significa una fiscalización proactiva. Que incluya una actualización y capacitación permanente de los auditores, que son claves para estos procesos.
A propósito de los retos que representa la inversión en tecnología para las instituciones públicas en una región como América Latina, el Índice Latinoamericano de Inteligencia Artificial (ILIA) 2025, publica-
do por la CEPAL, destaca que América Latina, paradójicamente, considerando las múltiples desigualdades que aún debemos superar, tiene resultados favorables en la adopción de la IA, identificando oportunidades para ecosistemas digitales más robustos.
En países como México, Brasil y Chile, los repositorios de sistemas de IA en el sector público muestran iniciativas que optimizan la supervisión
fiscal, vinculando big data con algoritmos avanzados para evaluar el cumplimiento de normativas y políticas públicas.
A la par, la integración de IA enfrenta desafíos significativos, tanto en materia de ciberseguridad como en la necesidad de establecer regulaciones específicas para sancionar su uso inapropiado y garantizar su alineación con principios éticos.
De ahí que la capacitación en competencias digitales y éticas se vuelva crucial. Esto sucede en la Auditoría Superior de la Federación (ASF), donde lo hemos desarrollado en todas las áreas auditoras, incluyendo la auditoría forense, en algunas incluso sin costo, con el talento de nuestro personal especializado. Paralelamente, las temáticas como ciberseguridad y la protección de datos se consolidan como fundamentales en el proceso de adopción tecnológica para la fiscalización, aspectos que hemos fortalecido en la
Nueva Auditoría. En estos procesos se deben fortalecer mecanismos de supervisión, ciberseguridad y soberanía de los datos para garantizar que la innovación tecnológica sume todos sus beneficios, pero con un mejor control de riesgos, con la condición de proteger a las instituciones de nuevos riesgos por la adopción tecnológica a sus procesos. El eje es nuestra área de sistemas. Al respecto, el Banco Interamericano de Desarrollo (BID), en su informe sobre Ciberseguridad en América Latina, subraya oportunidades para integrar encriptación y monitoreo continuo en los sistemas de rendición de cuentas, promoviendo la resiliencia operativa frente a amenazas digitales. En América Latina, podemos desarrollar herramientas de autoevaluación, como la “Gestión de la Integridad en las EFS”, para incluir medidas de ciberseguridad. Estas inicia-
tivas muestran un cambio hacia una supervisión que construye confianza pública al prevenir riesgos. En este sentido, en la Auditoría Superior de la Federación lideramos esfuerzos para implementar sistemas de gestión de calidad que integran IA y ciberseguridad, siendo referentes en la región por los avances que ya hemos desarrollado, reduciendo la probabilidad de irregularidades y elevando la sostenibilidad de los procesos de auditoría a partir del uso de herramientas tecnológicas; en particular, en el caso de ciberseguridad, en la ASF contamos con el nivel 3 de seguridad otorgado por el ICREA, el cual certifica centros de datos a nivel internacional. En última instancia, su fiscalización superior —al tiempo que fortalece la rendición de cuentas— ayuda a construir EFS con mejores capacidades, más eficaces y con mayor confianza por parte de la sociedad.

Lilia Arellano
“Sólo en el peor de los desastres conoce uno la auténtica valía de los hombres”: Santiago Posteguillo
●Desgracias previsibles
●Indolencia, incapacidad, irresponsabilidad en gobiernos
●Sheinbaum prefiere recibir reclamos sin castigar a responsables ●Tulum, de paraíso a una zona totalmente prohibida para turistas
Ciudad de México, 13 de octubre de 2025.- Las fuertes lluvias que han azotado fuertemente a cinco entidades de la República, y con menores daños en gran parte del territorio mexicano, dejaron un saldo con cifras oficiales y hasta el cierre de estas líneas, de 64 personas muertas y 65 desaparecidas, en Veracruz, Puebla, Querétaro, San Luis Potosí e Hidalgo. Ninguno de los gobernadores de estos estados puso atención a los reportes meteorológicos, se mostraron como siempre, indolentes, insensibles, incapaces y tales conductas siguen manteniéndolas pese a sostenerse en alerta por lo reportado ayer por los servicios tanto nacionales como los provenientes del extranjero. Se suman ahora Tamaulipas, otras regiones de San Luis Potosí y Querétaro. Las comisiones formadas para la protección civil se han mostrado totalmente ineficaces. No tomaron ninguna medida para la instalación de refugios, para alertar a la población con el fin de evitar todas esas decenas de muertos y desaparecidos. Pusieron en marcha el Plan DNIII-E del Ejército, con aquellas acciones tan admirables en las cuales vimos a nuestros militares enfrentar los desastres naturales, brindarle apoyo a la población afectada llevando no solamente artículos sino alimentación preparada y despensas. El dinero, los apoyos económicos necesarios salían de inmediato sin tanta bu-
rocracia del Fondo para Desastres Naturales (FONDEN) desaparecido por López Obrador acusando corrupción. Gobernación hacia la declaración de zona de desastre y de inmediato se procedía a entregar, por lo menos, lo indispensable. En estos días, los mílites están ocupados dizque “correteando” a las bandas delincuenciales y, por lo tanto, ya no tienen tanto personal para asignarlo a las tareas de recuperación de las zonas afectadas.
En su recorrido por las entidades en donde la tragedia está presente, la mandataria federal Claudia Sheinbaum enfrentó reclamos al igual que la gobernadora Rocío Nahle García: “¡No sirves para nada, ni la gobernadora!”. La mandataria les prometió: “nadie quedará sin ayuda”, ante las acusaciones de inacción de las autoridades, las cuales no se hicieron esperar. Ante un gobierno sin dirección ni estrategia ante fenómenos naturales, lo más grave es la falta de recursos para enfrentar los daños causados en más de cien municipios. Pese a la experiencia, suponemos dolosa y desagradable, la titular del Ejecutivo se mostró incapaz de lanzarle un reclamo a la Nahle, a Armenta, al “pollo” Gallardo, decidió cargar bajo sus hombros toda la culpa aun sin tenerla. Son inaceptables las excusas de no saber ni adivinar la magnitud del mensaje de la madre naturaleza, porque, repetimos, los servicios meteorológicos
son los mejores indicadores de lo que va a registrarse. Habría de citar a los de Protección Civil y dar a conocer si se trata de funcionarios preparados para esa función porque, en la mayoría de los casos, nombran a aquellos a quienes deben darle una chamba bien pagada por sus servicios en años anteriores. Un ejemplo claro se tuvo en Quintana Roo, en donde Carlos Manuel Joaquín González nombró en ese cargo a su exchofer, quien, además le daba servicios de seguridad a su familia antes de llegar a la gubernatura. Los gobernadores han demostrado una y otra vez su ignorancia, incapacidad, irresponsabilidad y la falta de experiencia para poder brindarles seguridad en cualquiera de los renglones a sus ciudadanos. ¿Hasta dónde y hasta cuando se seguirán aguantando los argumentos para defender lo indefendible? Los mandatarios estatales mencionados no tienen sino perversión y flojera, no debiera extenderse ese manto de impunidad cuando cargan decenas de cadáveres sobre sus hombros.
En la mañanera doña Claudia afirmó le consta el trabajo de todos los gobernadores, pero eso fue cuando la desgracia estaba presente, antes hicieron oídos sordos a los reportes en donde los alertaban de las dimensiones de las tormentas. Es absurdo que, conociendo cuando se presentan las temporadas de lluvia, no se tomen las medidas adecuadas. Igual sucede cuando se sabe del inicio y el final de la temporada de huracanes. Año tras año es lo mismo, nada cambia y quienes ofrecieron ser distintos lo han sido, sí, pero para generar mayores tragedias que sus antecesores.
Pruebas y ejemplos los han dado los pobladores de las entidades afectadas cuando, frente a CS reclamaron: “No está haciendo nada la gobernadora”, gritó
una mujer. La mandataria pidió paciencia a los afectados porque, según dijo, era imposible arreglar todo de manera inmediata. “El Ejército no quiere entrar a las casas. Hay familias que aún no reciben ayuda”, dijo un poblador. Ante los reclamos, Sheinbaum Pardo subió a una camioneta del Ejército y exclamó: “Escúchenme, escúchenme”. Mientras, un joven exigía información sobre sus tres compañeros de la Universidad Veracruzana (UV): “Mis compañeros estudiantes no pudieron salir. Ya pasaron tres días y no aparecen. De qué me sirve que venga aquí; yo quiero ver a mis compañeros”, clamó el joven. La mandataria dijo que habría un informe detallado de daños y que nadie quedaría sin ayuda. Han pasado 30 horas de esa visita y todo sigue igual. El comportamiento indolente de Alejandro Armenta, gobernador de Puebla, no fue diferente al de la zacatecana Nahle, inexplicablemente gobernadora de Veracruz. Por la que respecta a San Luis Potosí, resultaron 12 municipios afectados y se ve a los de la Guardia Civil recorrer estos lugares, aunque siguen enclavados en la capital en donde lo importante es no dejar de lado las percepciones económicas de los socios de la familia Gallardo. Como ha sucedido con otros desastres como temblores, terremotos e inclusive con la explosión de la pipa en el puente La Concordia, son los ciudadanos quienes aportan alimentos, cobijas, papel sanitario, leche, ropa, para aliviar parte de las necesidades de los afectados. Cínicamente diputados y senadores ofrecen sus instalaciones para convertirlas en centros de acopio, cuando el pago de nuestros impuestos, ahora sin oportunidad de defender cobros indebidos ante la cancelación de amparos, debería ser suficiente para remediar estos y otros males. En el
México real, las obras de Kafka son cuentos infantiles.
DE LOS PASILLOS Tulum, Quintana Roo, enfrenta, para no variar, otra gran desgracia. No tienen turistas, deben salir los prestadores de servicio a ofrecer disculpas por el mal trato brindado al turismo extranjero y la discriminación a los nacionales. Aceptaron sin chistar el recorrido del presidente municipal Diego Castañón por las playas señalando son públicas, pero no deben sino utilizar aquellas destinadas para los pobladores siempre y cuando no lleven ni una botella de agua, ni nevera, ni alimentos, todo lo deben comprar con el concesionario, lo requerido: sombrillas, mesas, etcétera. Por si fuera poco, cambiaron el gran simbolismo de la zona arqueológica por una escultura ridícula. Este alcalde, como ningún otro, ha llevado al lugar a vivir la peor de sus crisis contribuyendo, además, con la falta de control en los precios tanto en restaurantes como con los taxistas, llevando la corrupción a los extremos. La venta de droga, el cobro de piso, las extorsiones están a la orden del día y el exfutbolista presume sus constantes viajes al extranjero. Es este uno de los ejemplos del porqué en esa entidad aborrecen a los del Partido Verde. ¿Con estos personajes pretenden hacerse de la gubernatura?
Lo invitamos a visitar nuestras redes: https://www.youtube.com/ mxntelevision
https://www.youtube.com/ Liliaarellano
https://www.facebook. com/1liliaarellano
https://www.twitter.com/lilia_arellano1
https://t.me/mxnradioytv https://instagram.com/liliaarellanooficiala
La búsqueda de El Dorado causó la pérdida de vidas e incluso provocó muertes. Pero, ¿existió realmente?

El Dorado, la legendaria “ciudad perdida del oro”, ocupa un lugar destacado en el mundo de las leyendas. Ha inspirado búsquedas, libros y películas a lo largo de toda una vida. Pero, ¿es real?
La codicia por el oro trasciende todas las épocas, razas y nacionalidades. Poseer cualquier cantidad de oro parece despertar un deseo insaciable de obtener más.
A lo largo de los siglos, esta pasión dio lugar a la perdurable leyenda de un lugar de inmensa riqueza gobernado por un soberano bañado en oro. En los siglos XVI y XVII, los europeos creían que esta ciudad dorada existía en algún lugar del “Nuevo Mundo”.
Su búsqueda de El Dorado y sus riquezas costó innumerables vidas, llevó al suicidio al menos a un hombre y condenó a otro a la guillotina. Pero la mítica ciudad nunca se ha encontrado.
“El Dorado cambió de ubicación geográfica hasta que finalmente pasó a significar simplemente una fuente de riquezas incalculables en algún lugar de América”, asegura Jim Griffith, folclorista de Tucson, Arizona (Estados Unidos).
Los orígenes de El Dorado
Los orígenes de El Dorado se remontan a lo más profundo de Sudamérica. Y, como todos los mitos perdurables, la historia de la legendaria ciudad contiene algunos fragmentos de verdad.
Cuando los exploradores españoles llegaron a Sudamérica a principios del siglo XVI, oyeron historias sobre una tribu de nativos que vivía en lo alto de los Andes, en la actual Colombia. Cuando un nuevo jefe tribal ascendía al poder, su reinado comenzaba con una ceremonia en el lago Guatavita.
Los relatos sobre la ceremonia varían, pero todos coinciden en que el nuevo gobernante se cubrió de polvo de oro y que se arrojaron oro y joyas preciosas al lago para apaciguar a un dios que vivía bajo el agua. Los españoles comenzaron a llamar a este jefe dorado Eldorado. La ceremonia del hombre dorado supuestamente terminó a finales del siglo XV, cuando él y sus súbditos fueron conquistados por otra tribu. Pero los españoles y otros europeos habían encontrado tanto oro entre los nativos de la costa norte del continente que creían que tenía que haber un lugar de gran riqueza en algún lugar del interior. Los españoles no encontraron esta ciudad dorada. Sin embargo, sí encontraron el lago Guatavita e intentaron drenarlo en 1545. Bajaron su nivel lo
suficiente como para encontrar cientos de piezas de oro a lo largo de la orilla del lago. Pero el supuesto fabuloso tesoro que se encontraba en las aguas más profundas estaba fuera de su alcance.
La expedición de Sir Walter Raleigh a El Dorado
Los conquistadores españoles, entre ellos Gonzalo Jiménez de Quesada y Francisco de Orellana, así como el explorador alemán Philipp von Hutten, lanzaron expediciones para buscar la ciudad dorada. El cortesano inglés Sir Walter Raleigh realizó dos viajes a Guayana para buscar El Dorado. Durante su segundo viaje, en 1617, envió a su hijo, Watt Raleigh, con una expedición río arriba por el Orinoco. Pero Walter Raleigh, ya anciano, se quedó en el campamento base de la isla de Trinidad. La expedición fue un desastre y Watt Raleigh murió en una batalla con los españoles. Eric Klingelhofer, arqueólogo de la Universidad Mercer en Macon, Georgia, buscó el emplazamiento del campamento base de Raleigh en Trinidad. Afirma que Walter Raleigh se enfureció tanto con el superviviente que le informó de la muerte de Watt que lo acusó de haber dejado que mataran a su hijo. “El hombre entró en su camarote del barco y se quitó la vida”, cuenta Klingelhofer. Raleigh regresó a Inglaterra, donde el rey Jacobo ordenó que lo decapitaran por, entre otras cosas, desobedecer las órdenes de evitar el conflicto con los españoles.
El impacto perdurable de El Dorado
Hoy en día, la escurridiza ciudad bañada en oro sigue despertando la imaginación, desde los textos clásicos hasta las películas y los videojuegos modernos. La leyenda de El Dorado perdura porque “queremos que sea cierta”, afirma José Oliver, profesor del Instituto de Arqueología de la University College London. “No creo que hayamos dejado nunca de buscar El Dorado”. Entonces, ¿dónde está esta ciudad perdida del oro? En su poema de 1849 “El Dorado”, el escritor Edgar Allan Poe ofrece una sugerencia inquietante y elocuente: “Más allá de las montañas de la Luna, en el fondo del valle de las sombras, cabalgad, cabalgad sin descanso... si buscáis El Dorado”.
Santoral: Calixto, Donaciano, Fortunato
DÍA MUNDIAL DE LA COSTURERA
Día Mundial de la Donación de Órganos, Tejidos y Trasplantes
Día Mundial de la Espirometría
Día Internacional de Ada Lovelace (Segundo Martes de Octubre)

El Día Mundial de la Costurera se celebra el 14 de octubre. Es un día para reconocer y agradecer el arduo trabajo, la habilidad y la creatividad de quienes, con aguja e hilo, dan vida a prendas y reparan ropa.
Puntos clave de la celebración:
Reconocimiento: La jornada rinde homenaje al arte ancestral y la dedicación de las personas que se dedican a este oficio, ya sea en la industria textil o de forma independiente desde sus hogares. Origen incierto: Aunque la celebración es ampliamente reconocida en muchos países, el origen exacto y oficial de la fecha no está documentado con certeza.
Patronos:
Santa Lucía: Se la considera la patrona de las modistas y costureras, cuya festividad es el 13 de diciembre.
San Vicente Mártir: Simboliza la dedicación en esta noble labor y es considerado el santo patrón de costureras, sastres y modistas.
Acontecimientos Históricos:
• 1526: Se celebra en la ciudad de Texcoco (México), el primer casamiento religioso.
• 1789: George Washington proclama el primer “Día de Acción de Gracias” en EE. UU.
• 1811: Las cabezas de los insurgentes Hidalgo, Aldama, Allende y Jiménez llegan a Guanajuato para ser exhibidas en la alhóndiga de Granaditas, como advertencia.
• 1813: La ciudad de Caracas confiere a Simón Bolívar el título de "Libertador".
• 1814: Se integra el Congreso de Apatzingán, aprobando el decreto constitucional para la libertad de América Mexicana (la Constitución de Apatzingán).
• 1832: El físico estadounidense Samuel Morse inventa el telégrafo eléctrico y crea el alfabeto que lleva su nombre.
• 1884: En EE. UU., George Eastman (fundador de Kodak) recibe la patente para su nueva "película fotográfica" sobre una superficie flexible, revolucionando la fotografía.
• 1925: El Presidente Plutarco Elías Calles promulga el Decreto que declara a Don Francisco I. Madero Benemérito de la Patria.
• 1947: El piloto americano Chuck Yeager rompe por primera vez la barrera del sonido a bordo del avión cohete Bell "X-1".
• 1962: Un avión U-2 fotografía la construcción de bases soviéticas en Cuba, dando inicio a la Crisis de los Misiles.
• 1964: Martin Luther King Jr. gana el Premio Nobel de la Paz.
• 2012: Félix Baumgartner bate tres récords históricos al lanzarse en caída libre desde la estratosfera, superando la velocidad del sonido.
• 2023: Aparición de un Eclipse Solar denominado ‘Anillo de Fuego’.
Nacimientos destacados:
• 1503: Michel de Nostradamus (Astrólogo y matemático francés).
• 1890: Dwight David Eisenhower (Presidente de los Estados Unidos).
• 1927: Roger Moore (Actor británico, famoso por interpretar a James Bond).
Fallecimientos destacados:
• 1536: Garcilaso de la Vega (Militar y poeta español).
• 1944: Erwin Rommel, el "zorro del desierto", pone fin a su vida tras ser vinculado a un complot contra Hitler.
• 1990: Leonard Bernstein (Compositor y director, autor de "West Side Story").
• 2002: Norbert Schulz (Compositor alemán, autor de "Lili Marleen").
www.contactohoy.com.mx

Durango, Dgo.- Un policía jubilado murió este martes por la mañana en el Parque Guadiana, al ser víctima de un aparente infarto agudo al miocardio; la víctima realizaba ejercicio cuando ocurrió la tragedia.
La persona fallecida fue identificada como Héctor Hernández, un policía vial recientemente jubilado que pasó más de dos décadas como parte del Departamento de Accidentes de la Dirección Municipal de Seguridad Pública. De acuerdo a los datos recopilados, fue otro usuario del parque quien, al encontrarse en el área de ejercicios ubicada cerca de la trotapista, notó que el varón estaba inconsciente y se le acercó para
preguntar si le pasaba algo. Dado que no obtuvo respuesta, llamó de inmediato al número de emergencias y al sitio acudió una ambulancia de la Coordinación Estatal de Protección Civil. Su personal se acercó a la víctima y, al valorarla, ya no encontró signos vitales, pues al parecer había sufrido un infarto agudo al miocardio varios minutos atrás. Fueron sus propios compañeros policías que acudieron a la escena quienes, al ver los restos, identificaron a la víctima y confirmaron que se trataba de Héctor Hernández. Del cuerpo quedó a cargo la Fiscalía General del Estado para la necropsia de ley.

Murió varón que resultó quemado en polvorín
Durango, Dgo.- Este martes se confirmó la muerte del hombre que, el pasado jueves 9 de octubre, fue víctima de quemaduras severas junto a un polvorín del municipio de Santiago Papasquiaro cuando quemaba
los residuos de la fabricación de pirotecnia.
El fallecido es Carlos Alberto Ruacho Herrera, de 34 años de edad, quien tenía su domicilio en la colonia Lomas del Tepeyac de Santiago Papasquiaro;
era empleado de una empresa de pirotecnia ubicada en dicha demarcación, propiedad de su familia.
Los hechos ocurrieron en un predio habilitado como polvorín a la altura del kilómetro 5

del camino al rancho conocido como El Alamillo, en territorio del ejido 10 de Abril de Santiago Papasquiaro. Ahí, Carlos quemó los residuos de algunos trabajos de pirotecnia realizados el jueves, como hacía habitualmente, y en éstos al parecer había pólvora excesiva.
Cuando les lanzó un cerillo generaron un fuerte flamazo
que alcanzó a la víctima, que resultó con quemaduras en el 75 por ciento de su cuerpo, por lo que lo subieron a un vehículo particular y lo llevaron al Hospital General de Santiago Papasquiaro y después al Hospital General 450. Por desgracia, su condición no mejoró como se deseaba y este martes se confirmó su fallecimiento.

Mezquital, Dgo.- Por causas hasta ahora no detalladas, un hombre adulto fue víctima de heridas de bala a manos de un sujeto que, aunque ya está plenamente identificado, logró darse a la fuga. Los hechos ocurrieron en El Mezquital.
Según la información disponible, el incidente se dio en la localidad de Paura, de la menciona-
da demarcación el pasado domingo por la tarde, en circunstancias hasta ahora no precisadas. Ahí se habría dado una discusión en medio de la cual Óscar R. R., de edad no precisada, sacó un arma de fuego con la que atacó a José García Nájera, para después darse a la fuga. Tras la agresión, la víctima fue llevada de urgencia al Hospital
Integral de Mezquital, mientras que el presunto agresor subió a su camioneta Chevrolet, al parecer Yukón, y huyó en dirección a la ciudad de Durango.
Dada la gravedad de José, se le derivó al Hospital General 450, mientras que la Policía Investigadora abrió una indagatoria para dar con el paradero del presunto atacante.
Durango, Dgo.- Un hombre de unos 45 años de edad fue rescatado por policías que lo encontraron en medio de una visible crisis emocional caminando entre las aguas del arroyo Temazcal, en el norte de la ciudad.
La víctima, cuyos datos no fueron difundidos, quedó a cargo del personal de Trabajo Social de la Dirección Municipal de Seguridad Pública, que dará seguimiento al caso.
Fue poco después de las 22:00 horas del lunes cuando habitantes de la colonia Morga alertaron sobre la presencia del varón en el lecho del canal que atraviesa la zona, en medio de una visible crisis de salud mental.
Los oficiales llegaron al lugar y, tras algunos minutos de búsqueda, localizaron al individuo que, en efecto, se encontraba alterado.
Los agentes lo abordaron y, tras un diálogo de algunos minutos, lo convencieron de recibir ayuda y, en una patrulla, fue llevado al área correspondiente, donde se pusieron en contacto con sus familiares, que asumieron su resguardo y se comprometieron a atender la crisis de salud mental.



Topia, Dgo.- Policías municipales detuvieron a un individuo que portaba una pistola con su cargador completamente abastecido; su detección se dio porque, en un recorrido, los agentes lo vieron orinando.
El detenido es Yeirin “N”, con 25 años de edad y domicilio en la cabecera municipal de Santiago Papasquiaro, pero que se encontraba en el municipio de Topia cuando ocurrió el ilícito.
Según el informe, los agentes recorrían la calle Hidalgo, vía principal de la cabecera de Topia, cuando notaron que el varón estaba junto a una pared realizando sus necesidades fisiológicas.
Una vez que los agentes se detuvieron frente a él, el tipo se echó a correr y en el camino arrojó al suelo un arma de fuego; la persecución siguió y lo alcanzaron instantes después para así asegurarlo.
Los agentes revisaron la pistola de la marca Luger, en cuyo cargador había ocho cartuchos útiles calibre .22.
El individuo, tras el arresto, fue entregado al Ministerio Público, que realiza las diligencias por la portación ilegal de arma de fuego.
En sala Del Carmen se está velando el cuerpo de la Sra. María del Carmen Rodríguez González, de 59 años, sus honras y sepelio están pendientes
En sala Espíritu Santo se está velando el cuerpo del Sr. José Marcelino Espino Astorga, de 58 años, sus honras y sepelio están pendientes
En sala Resurrección se está velando el cuerpo de la Sra. Alma Delia Hernández Hernández, de 51 años, sus honras y sepelio están pendientes
En capilla #5 de matriz 5 de Febrero se está velando el cuerpo de la Sra. María Ortiz Pérez, de 90 años, sus honras y sepelio están pendientes
En capilla de domicilio conocido en Santiago Papasquiaro, Dgo., se está velando el cuerpo del Sr. Carlos Alberto Roacho Herrera, de 34 años, sus honras y sepelio están pendientes
En domicilio conocido en Mpio. Canatlán, Dgo., se está velando el cuerpo de la Sra. María Arciniega Rochel, de 74 años, sus honras y sepelio están pendientes
En domicilio conocido en El Pino, Durango, Dgo., se está velando el cuerpo del Sr. Luis Mendoza Ibarra, de 80 años, sus honras y sepelio están pendientes
Poanas, Dgo.- Un hombre de 41 años de edad murió en el municipio de Poanas, luego de ser víctima de una aparente congestión alcohólica; su cuerpo, ya sin signos vitales, fue encontrado a bordo de su camioneta.
El fallecido es Martín Córdova Castrejón, quien en vida tenía su domicilio en la localidad de Noria de los Pilares, de la mencionada demarcación del sur del estado.
De acuerdo a los datos recopilados por las autoridades, la víctima estuvo ingiriendo alcohol
durante varias horas y, al llegar a su casa, no alcanzó a ingresar y se quedó dormido en la camioneta. Sin embargo, nadie se dio cuenta de ello y no fue sino hasta el amanecer cuando su padre se acercó e intentó despertarlo, pero sin éxito. Ante ello llamó al número de emergencias buscando asistencia médica.
Al lugar acudió personal de la Cruz Roja Mexicana, pero Martín ya no tenía signos vitales; los indicios apuntan a que su deceso se derivó de una congestión alcohólica.

Gómez Palacio, Dgo.- Un hombre adulto murió en su domicilio del municipio de Gómez Palacio por una lesión que él mismo se provocó cuando se encontraba sin compañía; fue su joven hija quien lo encontró ya sin signos vitales.
La persona fallecida es el señor Jorge A. G., quien tenía 49 años de edad y vivía en el fraccionamiento Santa Teresa, ubicado en la zona urbana de la mencio-
nada demarcación. De acuerdo al testimonio de la hija de la víctima, una joven de 20 años de edad, su padre había pasado varias horas ingiriendo alcohol al exterior de su domicilio, mientras ella estaba en el interior. En determinado momento, decidió salir a buscarlo para que descansara y dejara de beber, pero al asomarse en la cochera, lo encontró inconsciente, víctima de una clara autolesión, por lo que
al tiempo que pedía ayuda inició maniobras para reanimarlo.
Poco después llegó la Cruz Roja Mexicana, pero tanto los esfuerzos de la joven como de los paramédicos fueron inútiles, pues Jorge tenía ya un rato sin signos vitales.
Cabe recordar que a través del 911 se brinda apoyo emergente a personas en situación de crisis emocional.

bordo de su motocicleta.
sito ocurrido en el bulevar José María Patoni, cuando circulaba a
La víctima es un hombre que, al momento del percance, conducía una motocicleta Itálika FT125. Fue a la altura de la maquila

Daws, ubicada en Ciudad Industrial, donde se dio una colisión entre el vehículo ligero y un automóvil Chevrolet Sonic conducido por José S., de 69 años de edad. Producto del impacto, que al parecer fue leve, el motociclista perdió por completo el control de la unidad y cayó aparatosamente; dado que no portaba casco, se golpeó de lleno la cabeza contra el pavimento.
Eso le ocasionó un traumatismo craneoencefálico severo que lo dejó inconsciente, por lo que de inmediato fue llevado en ambulancia al Hospital General 450, donde su pronóstico es reservado.
Murió solo en su casa de la Niños Héroes

Durango, Dgo.- Un adulto mayor fue encontrado muerto en un domicilio de la zona norte de la ciudad; fue un vecino quien, al percibir olores fétidos, se acercó para revisar lo que ocurría y descubrió el cadáver.
Los datos de la víctima no han sido informados, aunque se confirmó que el ahora occiso era un hombre de edad avanzada que vivía sin compañía en un domicilio de la colonia Niños Héroes.
Fue un vecino de 44 años quien el lunes, tras varios días sin ver a su vecino y al percibir olores fétidos, decidió acercarse a
Fue así que notó que la víctima estaba inconsciente dentro del inmueble y solicitó la presencia de los cuerpos de auxilio, que llegaron poco después y confirmaron la defunción.
El cuerpo, según lo observado por el personal policial, tenía al menos 4 ó 5 días sin vida, tiempo en el que nadie lo visitó. De sus restos se hizo cargo el Servicio Médico Forense, que confirmó que la defunción se derivó por causas naturales.
Despertó y encontró a su marido muerto en el patio
Indé, Dgo.- Un quincuagenario murió en el municipio de Indé a causa de una lesión que, según los indicios, él mismo se causó; fue su esposa quien lo encontró sin signos vitales tras despertar y no encontrarlo con ella en la habitación.
El fallecido es el señor Humberto, de 59 años de edad y domicilio en el Callejón Aldama de la mencionada cabecera municipal. Según el informe, su esposa despertó de madrugada y le extraño que su marido no estuviera con ella, por lo que tras unos minutos, decidió buscarlo; dado que no lo encontró en el baño, ni en la sala, salió al patio de la vivienda.
Fue así que lo encontró inconsciente, por lo que le gritó al hijo de ambos con la intención de reanimar a la víctima, pero esto no fue posible, pues para ese momento ya no contaba con signos vitales. Una vez confirmada la defunción, se hizo cargo de los restos personal de la Fiscalía General del Estado para su traslado al anfiteatro, con el fin de realizar la necropsia de ley. Es de apuntar que en el 911 se brinda apoyo emergente a cualquier persona que se encuentre en alguna crisis de ansiedad o suicida.





El ciclista mexicano, Isaac del Toro, continúa su ascenso en la élite del ciclismo internacional. El pedalista del UAE Team Emirates subió un puesto en la clasificación de la Unión Ciclista Internacional (UCI) y ahora ocupa el tercer lugar mundial, solo por detrás del esloveno, Tadej Pogacar, y del danés, Jonas Vingegaard, dos de los grandes referentes del pelotón actual. De acuerdo con la última actualización del ranking, Del Toro suma 5,314 puntos, superando al danés Mads Pedersen (Lidl–Trek), que cayó al cuarto sitio con 5,074.45 unidades. Pogacar continúa como líder con 11,680 puntos, seguido de Vingegaard, quien cuenta con 5,944.14. El portugués, Joao Almeida, compañero de Isaac en el UAE Team Emirates, completa el top 5 con 4,331.07 puntos. El avance de Isaac del Toro confirma la proyección del joven mexicano de 21 años, quien ha tenido una temporada sobre-
saliente con 15 victorias, dos top ocho en el Campeonato Mundial y un segundo lugar en el Giro d’Italia 2025, donde se convirtió en el primer mexicano en portar la maglia rosa. Su regularidad y desempeño en las clásicas lo han colocado entre los ciclistas más exitosos del año.
En 2025, Del Toro consiguió nueve triunfos en carreras clásicas, quedándose a una sola victoria de igualar el récord histórico de Eddy Merckx de 1972. Entre sus logros destacan conquistas como la Milano-Torino, Giro della Toscana, Coppa Sabatini, Trofeo Matteotti, Giro dell’Emilia y el Gran Piemonte, certámenes donde su potencia y resistencia marcaron diferencia.
El mexicano también firmó una destacada actuación en el Giro de Lombardía, donde finalizó en el quinto lugar, su mejor resultado en un Monumento, siendo además clave en el triunfo de su líder Pogacar. Con ello, consolidó su posición como uno de los jóvenes más com-
pletos del ciclismo profesional y referente de la nueva generación de corredores latinoamericanos. La clasificación de la UCI también refleja movimientos importantes en otros pedalistas del continente. El ecuatoriano, Richard Carapaz (EF Education–EasyPost), descendió al puesto 34 con 1,807 puntos, mientras que el colombiano, Egan Bernal (Ineos Grenadiers), escaló 11 posiciones hasta el lugar 35, con 1,742.5 unidades, confirmando una ligera recuperación en su rendimiento. Con su ascenso al tercer lugar, Isaac del Toro se convierte en el ciclista latinoamericano mejor ubicado del mundo, un hecho sin precedentes para México. Su crecimiento ha sido constante desde su triunfo en el Tour de l’Avenir 2023, certamen donde también hizo historia al ganar todas las clasificaciones: general, por puntos, de montaña y mejor joven.

udáfrica regresará al escenario mundialista. La selección africana aseguró su boleto al Mundial de 2026 tras vencer 3-0 a Ruanda en la última jornada de las Eliminatorias, cerrando un ciclo lleno de tensión, altibajos y resiliencia. El triunfo selló una clasificación esperada, pero que se definió con sufrimiento hasta el final.
El combinado dirigido por Hugo Broos había visto comprometida su posición por un incidente administrativo: la alineación indebida de un jugador le costó tres puntos fundamentales. Aun así, el grupo se mantuvo firme, sumó resultados clave y terminó imponiéndose con autoridad en su zona.
El balance final fue positivo: cinco victorias, tres empates y dos derrotas, una de ellas dictada en el escritorio ante Lesoto. La consistencia del equipo fue suficiente para imponerse a potencias de la región, entre ellas Nigeria, que terminó relegada al segundo lugar del grupo.
Con esta clasificación, Sudáfrica volverá a disputar una Copa del Mundo después de 16 años. Su última participación fue en 2010, cuando fue sede del torneo y dejó una huella imborrable al convertirse en el primer país africano en organizarlo. El regreso representa un nuevo punto de partida para un equipo que busca consolidarse nuevamente entre las selecciones más competitivas del continente.
El proyecto de Hugo Broos, técnico belga con experiencia en selecciones africanas, apostó por un plantel joven y equilibrado. Bajo su mando, Sudáfrica fortaleció su estructura defensiva y mejoró su eficacia frente al arco

rival, dos aspectos que resultaron decisivos para alcanzar la clasificación.
La historia de Sudáfrica en los Mundiales comenzó en Francia 1998, donde debutó con una derrota 0-3 ante los anfitriones, pero mostró carácter al empatar con Dinamarca y Arabia Saudita. Aquella primera aparición marcó el inicio de su camino en el escenario más importante del fútbol.
En Corea Japón 2002 firmó su mejor desempeño hasta ahora. Empató con Paraguay, venció 1-0 a Eslovenia y cayó 3-2 ante España, quedando fuera por diferencia de goles. Ese torneo confirmó el
crecimiento del fútbol sudafricano en la escena internacional. Ya en 2010, como anfitrión, el conjunto local no logró avanzar a octavos, pero celebró una victoria histórica frente a Francia. Ahora, con su regreso al Mundial de 2026, Sudáfrica buscará superar por primera vez la fase de grupos y escribir un nuevo capítulo en su historia futbolística.
Senegal y Costa de Marfil también amarran su pase al Mundial de 2026
Senegal y Costa de Marfil también se unieron a la lista de las selecciones africanas que irán
a la próxima Copa del Mundo de 2026. Los Leones vencieron a Mauritania con una goleada de 4-0, en la última jornada de las eliminatorias, mientras que los Elefantes hicieron los deberes ante Kenia con un 3-0. Con el cierre de la jornada 10, África completó a sus nueve selecciones que irán al Mundial de 2026 con pase directo. Gabón, Congo, Burkina Faso y Camerún disputarán un playoff tras haber quedado entre los mejores cuatro segundos lugares. El ganador de esta eliminatoria acudirá al repechaje internacional para definir los últimos boletos de la competencia.
Los clasificados al Mundial por África
Estos son los equipos del continente africano que ya tienen asegurada su presencia en la Copa del Mundo de 2026: África (9) Marruecos
Túnez Egipto Argelia Ghana Cabo Verde Sudáfrica Senegal Costa de Marfil
La cuarta ronda de las eliminatorias mundialistas en Asia dejan dos calificados más: Qatar y Arabia Saudita, quienes vencieron a Emiratos Árabes Unidos e Irak, selecciones que irán por su boleto al repechaje en la siguiente ronda.
La pizarra de Lopetegui le da el boleto a Qatar Qatar estará en el Mundial por segunda edición consecutiva y por primera vez se gana el boleto en la cancha y no por ser sede, luego de vencer 2-1 a Emiratos Árabes Unidos en la ‘final’ de su grupo. El equipo dirigido por Julen Lopetegui llegó al último partido de la cuarta ronda con la obligación de ganar, ya que el empate en el estadio Jassim bin Hamad le hubiera dado el boleto a los Emiratos Árabes Unidos, y sufrieron hasta el último instante, pero dos tantos a balón parado valieron el boleto.
El primer tiempo dejó pocas opciones claras. Qatar buscó el área con centros hacia Almoez Ali y Al Mannai, mientras los Emiratos controlaron con posesiones largas y un aviso de Nicolás Giménez desde media distancia. El descanso llegó sin movimiento en el marcador y Qatar tenía 45 minutos para llegar al Mundial. El punto de inflexión llegó al 50’. Akram Afif ejecutó con precisión una pelota detenida y Boualem Khoukhi ganó por

arriba para el 1-0. Anotación que cambió todo, dándole oxígeno a los loclaes para gestionar el partido. Otro cabezazo amplió la diferencia.
Al 75’, de nueva cuenta en un tiro libre, una mala salida del guardameta Khalid Eisa, quien midió mal el balón a segundo poste, regaló el 2-0 a Pedro Miguel.
Parecía que Qatar navegaba por aguas tranquilas, con dos goles de ventaja, pero la expulsión de Tarek Salman complicó todo.
El árbitro añadió 15 minutos y se compicó el partido. Al 99’. Sultan Adil controló de pecho dentro del área y definió cruzado para el 2-1, un tanto que hizo que los últimos minutos tuvieran dosis extras de sufrimiento, pero no llegó el empate. El silbatazo final deja a Qatar en el Mundial del 2026, la segunda vez que participa en la historia tras ser sede en 2022, edición en la que se fueron sin puntos. Emiratos Árabes Unidos tendrá que jugar el repechaje asiático, donde
se jugará la vida por el pase. Lopetegui termina así la encomienda que tomó hace 16 meses. Asumió como entrenador de Qatar en el verano del 2024 y consiguió meterse a esta cuarta ronda. Les tocó el grupo con los Emiratos y Omán, sumando un empate y esta victoria que les permitirá estar en la justa mundialista que se disputará en México, Estados Unidos y Canadá.
Arabia Saudita vence a Irak
Arabia Saudita tuvo que su-
frir hasta el último minuto, pero consiguió empatar sin goles ante Irak, por lo que los dirigidos por Hervé Renard estarán de nueva cuenta en la justa mundialista, al sumar cuatro puntos en esta cuarta ronda. Ambas selecciones habían derrotado a Indonesia, pero Arabia Saudita lo hizo 3-2, por 1-0 de Irak, así que la diferencia de goles les mete al Mundial del 2026. Irak se jugará su boleto ante Emiratos Árabes Unidos, por un boleto al repechaje.

Cristiano Ronaldo volvió a dejar su huella en la historia del fútbol internacional. Este 14 de octubre, en el Estádio José Alvalade de Lisboa, el delantero portugués marcó un doblete ante Hungría y alcanzó una cifra inédita al convertirse en el máximo goleador en la historia de las eliminatorias mundialistas, con 41 anotaciones. Con ello rompió el empate que mantenía con el guatemalteco Carlos Ruiz, quien acumuló 39, y amplió su ventaja sobre Lionel Messi, que suma 36. El encuentro ante Hungría comenzó cuesta arriba para Portugal, que recibió un gol en los primeros minutos. La reacción
llegó al minuto 22, cuando Ronaldo apareció en el área para empatar. Nelson Semedo desbordó por la banda derecha y envió una diagonal que superó a toda la defensa húngara; el capitán portugués quedó solo frente a la portería y definió con un toque sencillo para anotar el tanto del 1-1. Con ese gol, alcanzó los 40 en procesos clasificatorios y rompió la igualdad con Ruiz en la lista histórica.
Poco antes del descanso, el jugador del Al Nassr volvió a aparecer para marcar el segundo tanto de la noche y dar ventaja a su selección. Ese doblete le permitió fijar el nuevo récord con 41 dia-
nas en partidos de clasificación a Copas del Mundo, una cifra que, a día de hoy, parece fuera del alcance de cualquier otro futbolista activo. Tras el segundo gol de Ronaldo, Portugal estaba encaminado para asegurar su boleto de forma anticipada. Sin embargo, Dominik Szoboszlai igualó el marcador al último minuto y prolongó la clasificación de los lusitanos .
El camino de Ronaldo en las eliminatorias comenzó en 2004, en el camino rumbo a Alemania 2006. En su debut marcó un gol y asistió otro en la victoria 2-0 sobre Letonia, con apenas 19 años. Desde entonces, ha disputado
cinco procesos clasificatorios consecutivos y ha anotado en cada uno, reflejo de una longevidad deportiva poco común. Para llegar a los 41 tantos, necesitó 51 partidos, mientras que el Pescadito alcanzó sus 39 en 47 apariciones. Entre sus rivales predilectos destacan Luxemburgo y Hungría. Contra los luxemburgueses acumula seis goles en cuatro enfrentamientos: uno en 2004, otro en 2012 y dos más durante el proceso rumbo a Catar 2022. Ante los húngaros suma ya cinco tantos en tres partidos, tras el doblete conseguido este martes en Lisboa, consolidando una vez más su eficacia frente a seleccio-
nes europeas de la zona media. Con esta nueva marca, Ronaldo amplía su dominio en los registros goleadores del fútbol de selecciones y reafirma su vigencia a los 40 años. Su récord en eliminatorias se suma a otros hitos como el de máximo goleador histórico a nivel internacional y el de jugador con más partidos con una selección nacional. La noche en Lisboa ratificó su papel central en la historia de Portugal y del fútbol mundial, un capítulo más en una carrera sin precedentes.
La selección inglesa se impuso a Letonia y aseguró su boleto a la Copa del Mundo 2026, que se celebrará en México, Estados Unidos y Canadá. Con marcador de 5-0, los Tres Leones de Thomas Tuchel amarraron el liderato del Grupo K en el Daugava Stadium de Riga, y mantienen paso perfecto con seis victorias en seis partidos.
Inglaterra se convirtió en el primer clasificado del continente europeo al torneo veraniego. El equipo disputará su séptima Copa del Mundo de forma consecutiva y la decimosexta en su historia, con el objetivo de superar los cuartos de final por primera vez desde que levantó el título en 1966, cuando fue anfitrión. El conjunto de Thomas Tuchel dominó todo el encuentro ante un rival en crisis, que no conoce la victoria desde la primera fecha del certamen clasificatorio. Al minuto 26, Anthony Gordon abrió el marcador con un golazo. El extremo del Newcastle recibió el balón por la banda izquierda, recortó hacia adentro y remató al segundo poste para poner el 1-0. La ventaja mínima parecía que se mantendría hasta el descanso. Sin embargo, Harry Kane apareció para aumentar la dife-

rencia antes del medio tiempo. El delantero, que atraviesa un gran momento de forma, marcó un doblete entre el 43 y el 45, con el que llegó a 76 goles con el combinado nacional y seis en las actuales eliminatorias. En la segunda mitad, los Tres
Leones mantuvieron el control del encuentro y ampliaron la ventaja con una jugada por la derecha que terminó en autogol de Maksims Tronisevs, al intentar despejar un centro al área chica. Más adelante, Eberechi Eze cerró el 5-0 definitivo con un remate de
pierna derecha tras un contragolpe bien ejecutado. Con el triunfo en Riga, Inglaterra llegó a 18 unidades, superando por siete a Albania, que ocupa el segundo puesto. Una diferencia que ya no puede ser alcanzada con solo dos jornadas por disputarse. Lo que aún está en juego es el boleto al repechaje: Albania mantiene la ventaja de una unidad sobre Serbia en la apasionante e intensa rivalidad balcánica, aunque Las Águilas aún tienen dos partidos para intentar revertir la diferencia.

Con dramatismo puro y con la angustia a flor de piel hasta la última bola, Los Angeles Dodgers derrotaron 2-1 a los Milwaukee Brewers, en el juego 1 de la Serie de Campeonato de la Liga Nacional, para ponerse adelante 1-0 en el American Family Field, dentro de los playoffs de la MLB. El equipo californiano supo aguantar la presión en el momento más complicado y salir de lo que parecía le cambiaría el rostro al partido en la última entrada, para ganar el primer duelo en calidad de visitante, en un triunfo que puede resultar vital para sus aspiraciones de llegar a la Serie Mundial 2025.
El juego entre Dodgers y Cerveceros además dejó una jugada insólita. Con las bases llenas, un batazo de Max Muncy provocó confusión tras rebotar en la barda del American Family Field, lo que derivó en una doble matanza validada tras revisión. Según la regla del parque, la bola siguió
viva al no tocar la franja azul del muro, permitiendo a Milwaukee concretar una de las jugadas más extrañas de la postemporada y apagar un posible grand slam de Los Ángeles.
Blake Snell tuvo una actuación por demás sobresaliente desde la loma, al lanzar una verdadera joya de partido, con 10 ponches y un solo hit en ocho entradas, dejando el destino del encuentro en los relevistas del equipo, quienes vivieron su momento de angustia, resistiendo el ataque final de los Cerveceros, que lograron ponerse 2-1, pero dejando las bases llenas en una dramática novena entrada.
Fue hasta la sexta entrada que Freddie Freeman se voló la barda con un batazo al jardín derecho, con el que los Dodgers se ponían en ventaja 1-0 y abrían un cerrado partido que hasta ese momento sólo veía ceros en la pizarra.
El juego, sin embargo, no cambió y las argollas siguieron
cayendo, hasta que en la parte alta de la novena entrada Los Angeles consiguieron el 2-0 con una carrera de caballito, tras cuatro bolas malas de Abner Uribe a Mookie Betts para que Max Muncy anotara y aumentara la diferencia.
El daño estaba hecho y los Cerveceros tenían la última oportunidad de intentar sacar el juego ante el japonés Roki Sasaki, quien ingresó de relevo, con la intención de finiquitar el duelo.
Jake Bauers vino como bateador emergente y pegó un doblete al jardín derecho por la regla de campo, quedándose Milwaukee con dos hombres en base y en posición de anotar.
Vino entonces Jackson Chourio, quien no esperó y conectó la pelota al primer lanzamiento, llevando a Collins al home con un pisa y corre que se convirtió en el 2-1. Era la locura en el American Family Field.
El turno de vestirse de héroe


llegó para Christian Yelich, quien recibió la base por bolas de Sasaki, quien tras esto fue retirado sin éxito en su relevo. Blake Treinen entró a la lomita para intentar parar a Milwaukee y sellar el triunfo de los Dodgers, enfrentando a William Contreras, con dos outs y hombres en segunda y tercera, terminando por llenar la casa. Más dramatismo no podía haber. Brice Turang llegó a la caja para definir al partido y así sucedió. Blake Treinen lo ponchó y le
dio la victoria a los Dodgers de manera angustiante. Ahora, los Dodgers tienen el peso de la historia a su favor. En la historia de la postemporada, los equipos que ganan el juego 1 de una serie al mejor de siete han terminado llevándose la serie en 126 de 194 ocasiones (64.9%). En el actual formato 2-3-2, los equipos que ganan el primer juego como visitantes han avanzado en 40 de 71 ocasiones (56.3%).

